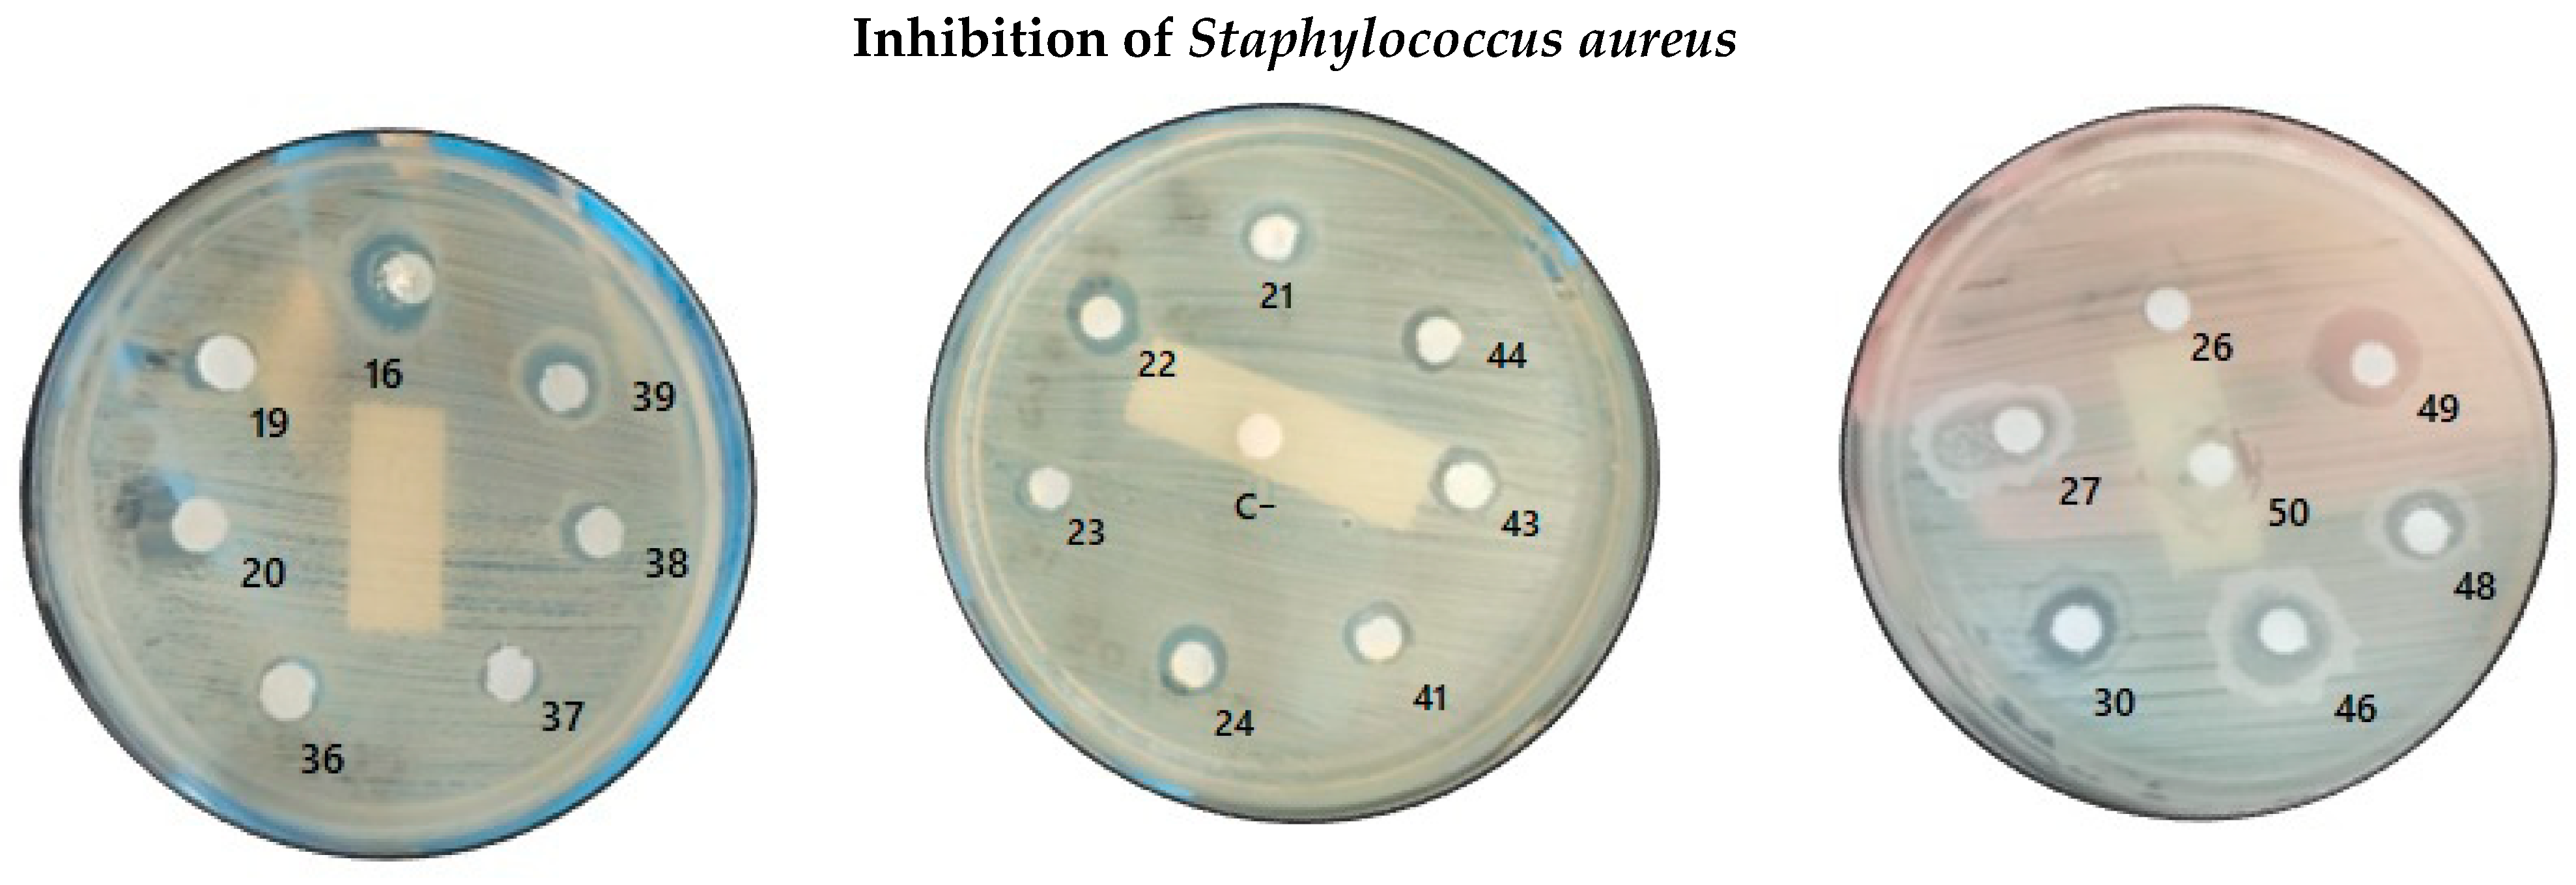
Molecules 31 00170 g004b Molecules 31 00170 g004b

Abstract
A collection of 40 derivatives of 1,2-diphenyl-2-[1,2,3]triazol-1-yl-ethanol was obtained through a sequence of reactions, starting with benzoin as the initial raw material and using the CuAAC reaction as the key step in this process. The structure of a pair of these compounds was ultimately corroborated by single-crystal X-ray diffraction studies, which also reveals important O-H···N interactions. The antimicrobial activity of synthesized 1,2,3-triazoles was assessed against strains that include Candida albicans and Staphylococcus aureus. The antiproliferative properties of some of these novel compounds were also tested using a variety of tumor cell lines, including U251 (human glioblastoma), PC-3 (human prostate cancer cell line), K562 (human leukemia), HCT-15 (human colorectal adenocarcinoma), MCF-7 (human breast adenocarcinoma), and SKLU (human lung adenocarcinoma).
1. Introduction
By definition, a privileged structure is a specific arrangement of atoms that exhibits a high affinity for binding to various biological molecules, often resulting in significant biological activity. These structures are considered “privileged” because they facilitate the discovery of new drugs by serving as templates or scaffolds for synthesizing compounds with therapeutic potential [1]. Some important examples of privileged structures include chalcones [2], quinones [3], curcuminoids [4,5] and morpholine [6].
On the other hand, benzoin and its derivatives constitute a relatively unexplored yet auspicious reservoir of biologically active molecules, exhibiting noteworthy antimicrobial, antioxidant and antitumor properties [7,8,9,10,11,12]. Moreover, benzoin is used as a framework in the preparation of pyrroles and oxazoles [13,14,15,16]. Some examples of biologically active benzoin derivatives, see Scheme 1, include Schiff Bases 1 and esters 2 with antiproliferative properties [10,11,17], potential antimicrobial and antioxidant pyrroles 3 [18], antimicrobial hydrazones 4 [19,20] as well as thiosemicarbazones 5 with antibacterial properties [21]. These characteristics hint at the potential use of benzoin as a privileged structure.
Scheme 1.
Structures of biologically active benzoin derivatives 1–5. The parts of these molecules derived from benzoin are highlighted in blue.
In another context, a widely used strategy in chemical synthesis is the copper-catalyzed azide-alkyne cycloaddition (CuAAC) which enables the fast and straightforward preparation of chemical libraries under mild conditions [22,23,24]. Through this approach, several biologically active molecules have been obtained, highlighting the development of 1,4-disubstituted-1,2,3-triazoles with antimicrobial [25,26,27,28,29,30,31,32,33,34,35,36] and antitumoral [37,38,39,40,41,42,43] properties.
Considering these facts, as well as our experience with the CuAAC reaction/Click Chemistry applied to the synthesis of biologically active 1,2,3-triazoles [44,45,46], we envisioned the benzoin structure as a molecular scaffold for preparing a novel family of 1,2,3-triazoles bearing to a 1,2-diphenyl motif. In this report, we disclose our most recent findings in this area, which we have outlined in the following sections.
2. Results and Discussion
A synthetic route for the titled compounds was designed using benzoin 1 as the starting material, as sketched in Scheme 2. In this route, benzoin 6 (R1 = H) was treated with thionyl chloride followed by sodium azide to give 2-azido-1,2-diphenyl-ethanone 8 which in turn was reacted with a series of alkyl magnesium bromides affording the respective 1-alkyl- 2-azido-1,2-diphenylethanol derivatives 9 that generate, under treatment with diverse alkynes and a CuI/DIPEA catalytic system, the corresponding 1,2-diphenyl-2-[1,2,3]triazol-1-yl-ethanol derivatives 10 (compounds 11–30) in yields ranged from 40% to 80%, see Table 1. Compounds 31–50 were prepared using a similar synthetic sequence from p-anisoin 7 (R1 = OMe), and their behavior was comparable to that of benzoin.
Scheme 2.
Synthetic route of 1,2-diphenyl-2-[1,2,3]triazol-1-yl-ethanol derivatives 10.
Table 1.
Synthesis of 1,2-diphenyl-2-[1,2,3]triazol-1-yl-ethanol derivatives.
The 1,2,3-triazoles 11–50 were fully characterized using conventional spectroscopic techniques. These techniques provided a set of signals that allowed for the structural elucidation of the compounds. Besides the signals in the NMR spectra that are characteristic of the 1,2,3-triazole ring—such as the appearance of a singlet signal corresponding to the hydrogen on triazole C-5 in the range of δ 7.4 to 8.8 ppm in the corresponding 1H NMR spectra—the 1H NMR spectra of these compounds also exhibit a singlet signal at approximately δ 5.5–6.0 ppm. This signal is associated with the methyne group bound to the N1 nitrogen atom of the 1,2,3-triazole core and to one of the phenyl groups.
Additionally, two characteristic signals appear in the 13C NMR spectra at approximately δ 146 and 121 ppm, which are assigned to C4 and C5 of the triazole moiety. Another noteworthy spectroscopic feature that distinguishes triazoles 11–50 is the presence of a quaternary aliphatic carbon signal at δ 79 ppm and a methyne carbon signal at δ 72 ppm in the respective 13C NMR spectra. Due to these signals, it is possible to generalize spectroscopically, allowing for the appropriate recognition of this novel class of 1,2,3-triazoles.
In this respect, compounds 11 and 30 were found to be crystalline solids, which were subjected to X-ray crystallography analysis, thereby substantiating the proposed structural model for these compounds. The ORTEP representations of compounds 11 and 30 are plotted in Figure 1 and the corresponding crystallographic data and structural refinement parameters are presented in Table 2.
Figure 1.
ORTEP diagrams for compounds 11 (a) and 30 (b).
Table 2.
Crystallographic data for the structural analysis of compounds 11 and 30.
The crystals of triazoles 11 and 30 belong to the monoclinic system with nonpolar, centrosymmetric phases. Compound 6 belongs to the P21/c space group, and compound 30 belongs to the P21/n space group. This means that for every atom in the structure, there is an identical atom located on the opposite side of the center of symmetry. These arrangements can be seen in the crystal packings projected in Figure 2. Consequently, the respective crystalline structures lack a permanent electric dipole moment because their unit cells have an inversion center. This behavior has been well-documented in some imines [47] and is likely due to the presence of racemic mixtures in these compounds [48].

Figure 2.
Crystal packing of compounds 11 (a) and 30 (b).
The crystal structures of triazoles 11 and 30 reveal significant O-H···N interactions that play a key role in shaping each structure. Compound 11 exhibits two important intermolecular interactions: one between the hydroxyl hydrogen atom and the N2 nitrogen atom, O1-H···N2 = 2.620 Å, and a second, closer intermolecular interaction between the hydroxyl hydrogen atom and the N3 nitrogen atom of the triazole moiety, O1-H···N3 = 2.027 Å, see Figure 3a. Compound 30, in contrast, has an intramolecular interaction O1-H···N2 = 2.096 Å as depicted in Figure 3b.
Figure 3.
O-H···N interactions in compounds 11 (a) and 30 (b).
The cytotoxic activity of 20 selected 1,2,3-triazoles was evaluated by quantifying their inhibitory activity on the growth of seven cell lines listed below: U251 = tumor cells derived from malignant glioblastoma, PC-3 = cell line derived from metastatic prostate cancer, K562 = cell line derived from myeloid leukemia, HCT-15 = cell line derived from colorectal adenocarcinoma, MCF-7 = cell line derived from breast cancer, SKLU-1 = cell line derived from lung adenocarcinoma and COS-7 = monkey kidney cell line (non-cancerous). Cytotoxic activity was assessed using the microcell culture method, which determines the endpoint of cell growth by staining with sulforhodamine B (SRB), a cell protein affinity dye, as described in the National Cancer Institute (NCI) protocols [49].
The results of the cytotoxicity tests are listed in Table 3. As can be seen, although almost all the evaluated compounds exhibit some degree of cytotoxicity in healthy, non-cancerous monkey kidney fibroblasts (COS-7), which makes them unsuitable in their current form as anticancer agents, some interesting trends can be established that may serve as a guide for the development of similar molecules. In this sense, it is worth noting that a significant decrease in cell inhibition percentage is observed for almost all triazoles with butyl alkyl chains compared to their ethyl alkyl chain counterparts in the U251, PC-3, and K562 cell lines. However, the opposite trend occurs with the HCT-15, MCF-7, SKLU-1, and COS-7 cell lines, since triazoles with longer chains generally show higher cell growth inhibition activity. Another direct comparison between the structure and cell growth inhibition percentage is promoted by the presence of methoxy substituents in compounds 31–40 derived from anisoin, where a decrease in cell growth inhibitory activity is observed compared to their much less polar counterparts derived from benzoin.
Table 3.
Growth inhibition (%) of tumor cell lines at 25 μM by compounds 11–20 and 31–40 1.
The antimicrobial activity of the synthesized 1,2,3-triazole derivatives was evaluated against Candida albicans and Staphylococcus aureus ATCC 29213, two clinically relevant pathogens frequently used as reference strains in antifungal and antibacterial susceptibility tests. The agar diffusion method was performed following the CLSI guidelines, using ketoconazole (25 µg/mL) and amikacin (30 µg) as positive controls, and methanol as the negative control [50]. The inhibition halos were measured after 24–48 h of incubation at 30 °C. The results of the antimicrobial activity tests are described only for the compounds that displayed inhibitory activity. The rest of the compounds were analyzed, and none of them showed significant activity.
The antimicrobial activity from the family of compounds 16–20 and 36–40 (R2 = butyl) is of particular interest. As shown in Figure 4 and Table 4, compound 16 displayed the largest diameters of zone of inhibition (DIZ) against C. albicans (15 mm), comparable to the positive control ketoconazole (15 mm at 25 µg/mL). Additionally, this compound exhibited antibacterial activity against S. aureus (11 mm), suggesting a dual effect that positions it as a promising candidate for further studies. Other members of this group (19, 20, 36–39) exhibited lower or moderate inhibition, ranging from 6 to 10 mm. Regarding a class of triazoles with R2 = Bn, several compounds demonstrated moderate antifungal effects. Compounds 22, 23, and 24 produced DIZ = 10 and 12 mm against C. albicans, whereas their activity against S. aureus was less pronounced, generally not exceeding 8 mm. This indicates that structural features in this family may favor antifungal rather than antibacterial activity.

Figure 4.
Diameters of inhibition zones of C. albicans and S. aureus culture on inoculation of selected 1,2,3-triazoles.
Table 4.
Values of diameter of the inhibition zone in mm for selected compounds.
Interestingly, the activity of 1,2,3-triazoles 46–50 derived from 1-azido-1,2-bis-(4-methoxy-phenyl)-5-methyl-hexan-2-ol (R1 = OMe, R2 = CH2CH2CH(CH3)), especially 50, suggests a promising dual antifungal–antibacterial effect, with inhibition halos consistently reaching 13 mm in both C. albicans and S. aureus. Similarly, compound 46 displayed dual activity (DIZ = 10 mm for fungi and 13 mm for bacteria). These results highlight the potential of this sort of compounds as a source of broad-spectrum antimicrobial agents. This dual action aligns with a previous work by Sari and coworkers, who reported the antibacterial activity of certain azole derivatives against S. aureus and E. faecalis with MIC < 1 µg/mL and negligible cytotoxicity. They proposed a mechanism involving the inhibition of bacterial flavohemoglobins, which is supported by docking studies [51]. This supports the potential expansion of azole applications beyond classical antifungal therapy.
In contrast, ethyl derivatives, compounds 11–15 and 31–35, showed limited activity. Only compound 15 exhibited detectable inhibition (DIZ = 8 mm for fungi, DIZ = 6 mm for bacteria), while the rest of the series were inactive under the experimental conditions tested. Similarly, cyclohexyl derivatives 26–30 presented weak to moderate inhibition, with inhibition halos ranging from 5 to 10 mm.
These results confirm that the synthesized 1,2,3-triazole derivatives exhibit variable antimicrobial effects depending on their structural family. Molecules with butyl and s-butyl substituents demonstrated the highest potential, with compounds 16 and 50 showing inhibition halos comparable to reference drugs. The activity against C. albicans was more consistent across families, while only selected derivatives displayed notable antibacterial effects. These findings suggest that structural optimization of triazole families with butyl and s-butyl substituents could further enhance their antimicrobial efficacy and support their candidacy for subsequent biological evaluations. Overall, these results confirm that the inhibitory potential of triazole-derived compounds depends strongly on structural modifications and their interaction with microbial targets. Molecules with butyl and s-butyl substituents display comparable inhibition levels to ketoconazole, which has dual antimicrobial effects. These molecules are promising candidates for further optimization and integration into drug delivery platforms.
Although it is difficult to make a comparison of the antimicrobial activity of the synthesized triazoles with respect to other benzoin derivatives due to the different protocols used for the evaluation of biological activity, it can be seen in general terms that the presence of the 1,2,3-triazole ring increases the antibacterial and antifungal activity compared to moieties [19,20,21].
These examples demonstrate the synthetic value of the benzoin structure as a scaffold and departure point for obtaining new molecules with biological activity. To our knowledge, these are the first 1,2,3-triazoles derived from 1,2-diaryl-2-azido-1-alkyl-ethan-1-ol prepared via the CuAAC reaction from benzoin/anisoin in a sequence of only 4 reaction steps.
3. Materials and Methods
3.1. General Remarks
The starting materials were purchased from Aldrich Chemical Co. (Milwakee, WI, USA) and were used without further purification. The solvents were distilled before use. Silica plates of 0.20 mm thickness were used for thin layer chromatography. Melting points were determined with a Kruss Optronic melting point apparatus (Kruss GmbH, Hamburg, Germany) and were uncorrected. 1H and 13C NMR spectra were recorded using a Bruker Avance 300 MHz (Bruker Corporation, Billerica, MA, USA); the chemical shifts (δ) were given in ppm relative to TMS as an internal standard (0.00). For analytical purposes, the mass spectra were recorded on a JEOL AccuTOF JMS-T100LP (JEOL Ltd., Tokyo, Japan) device in the DART mode via a direct inlet probe. IR spectra were recorded on a Bruker Tensor 27 (Bruker Corporation, Billerica, MA, USA). (Compounds spectroscopic data are in Supplementary Materials).
For the X-ray diffraction studies, crystals of compounds 2 and 25 were obtained by the slow evaporation of a dilute AcOEt solution, and the reflections were acquired with a Bruker APEX DUO (Bruker Corporation, Billerica, MA, USA) diffractometer equipped with an Apex II CCD detector, with Mo Kα radiation (λ = 0.71073 A) at 100 K. Frames were collected using omega scans and integrated with SAINT, and multi-scan absorption correction (SADABS) was applied [52]. The structures were solved by direct methods (SHELXS-97) [53]; missing atoms were found by difference-Fourier synthesis and refined on F2 by a full-matrix least-squares procedure using anisotropic displacement parameters using SHELXL [54] and the ShelXle GUI [55]. The hydrogen atoms of the C–H bonds were placed in idealized positions. The molecular graphics were prepared using Mercury (version 2022.3.0) [56] and POV-Ray (version 3.6) [57]. Crystallographic data for the structure reported in this paper have been deposited with the Cambridge Crystallographic Data Centre, CCDC (No. 2517822 for compound 11 and No. 2517823 for compound 30). Copies of available materials can be obtained free of charge on application to the Director, CCDC, 12 Union Road, Cambridge CB2 IEZ, UK (facsimile: (44) 01223 336033); e-mail: deposit@ccdc.ac.uk).
3.2. General Procedure for the Synthesis of 2-Diphenyl-2-[1,2,3]triazol-1-yl-ethanol Derivatives
Typical procedure. The appropriate azido alcohol (1 mmol) was added to a mixture of PEG-400 (3.2 mL) and H2O (0.8 mL), which was then gently warmed until the azido alcohol was fully dissolved. CuBr (0.014 g, 0.1 mmol), sodium ascorbate (0.019 g, 0.1 mmol), DIPEA (0.07 mL, 0.051 g, 0.4 mmol) and the corresponding alkyne (1.5 mmol) were added successively and the resulting mixture was stirred at 38–45 °C overnight. The mixture was cooled to room temperature and H2O (40 mL) was added. The product was filtered and washed with cold H2O. The solid was dissolved with a mixture 1:1 THF/AcOEt (10 mL) and dried over CaCl2. The mixture was filtered through a short silica column, the solvent was removed under reduced pressure and the product was purified by crystallization.
- 1,2-Diphenyl-1-(4-phenyl-[1,2,3]triazol-1-yl)-butan-2-ol (11)
1-Azido-1,2-diphenyl-butan-2-ol and phenylacetylene afforded 1,2-diphenyl-1-(4-phenyl-[1,2,3]triazol-1-yl)-butan-2-ol 11 as a white solid. Yield: 210 mg (57%), m.p. 196–197.5 °C. IR (ATR, cm−1): 3315, 3168, 3031, 2961, 2929, 1954, 1879, 1814, 1604, 1444. 1H NMR: (300 MHz, DMSO-d6) δ = 8.81 (s, 1H), 8.02–7.92 (m, 2H), 7.61–7.52 (m, 2H), 7.57–7.44 (m, 4H), 7.43–7.32 (m, 1H), 7.25 (t, J = 7.6 Hz, 2H), 7.23–7.08 (m, 4H), 6.30 (s, 1H), 5.71 (s, 1H), 2.07 (dq, J = 14.7, 7.4 Hz, 1H), 1.42 (dt, J = 14.3, 7.1 Hz, 1H), 0.59 (t, J = 7.3 Hz, 3H). 13C NMR: (75 MHz, DMSO-d6) δ = 146.59, 143.32, 137.16, 131.30, 130.16, 129.30, 128.28, 128.18, 128.04, 126.77, 126.60, 125.73, 122.00, 79.28, 72.59, 32.84, 8.10. HRMS (DART, [M+1]+) m/z calcd. For C24H24N3O: 370.1919; found: 370.1911.
- 1-(4-Cyclopropyl-[1,2,3]triazol-1-yl)-1,2-diphenyl-butan-2-ol (12)
1-Azido-1,2-diphenyl-butan-2-ol and cyclopropylacetylene afforded 1-(4-cyclopropyl-[1,2,3]triazol-1-yl)-1,2-diphenyl-butan-2-ol 12 as a white solid. Yield: 206 mg (62%), m.p. 171 °C. IR (ATR, cm−1): 3385, 3134, 3091, 2972, 2937, 1741, 1452, 1046, 819. 1H NMR: (300 MHz, CDCl3) δ = 7.43 (s, 1H), 7.23–6.91 (m, 10H), 5.59 (s, 1H), 3.97 (s, 1H), 2.04–1.79 (m, 2H), 1.46 (dq, J = 14.4, 7.3 Hz, 1H), 0.93–0.73 (m, 4H), 0.59 (t, J = 7.3 Hz, 3H). 13C NMR: (75 MHz, CDCl3) δ = 149.69, 141.11, 135.31, 128.87, 127.99, 127.82, 127.69, 126.91, 125.96, 121.75, 79.98, 73.74, 50.70, 32.84, 7.56, 6.68. HRMS (DART, [M+1]+) m/z calcd. For C21H24N3O: 334.1915; found: 334.1917.
- 2-[1-(2-Hydroxy-1,2-diphenyl-butyl)-[1,2,3]triazol-4-ylmethyl]-isoindole-1,3-dione (13)
1-Azido-1,2-diphenyl-butan-2-ol and 2-prop-2-ynyl-isoindole-1,3-dione afforded 2-[1-(2-hydroxy-1,2-diphenyl-butyl)-[1,2,3]triazol-4-ylmethyl]-isoindole-1,3-dione 13 as a white solid. Yield: 235 mg (52%), m.p.: 148.2–149 °C. IR (ATR, cm−1): 3496, 3292, 2969, 2939, 1711, 1395, 1094, 706. 1H NMR: (300 MHz, CDCl3) δ = 7.84–7.70 (m, 4H), 7.63 (dddd, J = 7.9, 6.9, 4.8, 4.0 Hz, 3H), 7.21–6.88 (m, 8H), 5.64 (s, 1H), 4.92 (s, 2H), 4.37 (d, J = 2.5 Hz, 1H), 1.94 (dq, J = 14.6, 7.3 Hz, 1H), 1.41 (dq, J = 14.3, 7.2 Hz, 1H), 0.56 (t, J = 7.3 Hz, 3H). 13C NMR: (75 MHz, CDCl3) δ = 167.68, 142.28, 140.97, 134.12, 132.05, 128.98, 128.02, 127.95, 127.76, 126.96, 125.95, 124.76, 123.49, 79.93, 74.06, 33.02, 27.00, 7.53. HRMS (DART, [M+1]+) m/z calcd. For C27H25N4O3: 453.1927; found: 453.1954.
- 1-[4-(2,6-Diisopropylphenoxymethyl)-[1,2,3]triazol-1-yl]-1,2-diphenyl-butan-2-ol (14)
1-Azido-1,2-diphenyl-butan-2-ol and 1,3-diisopropyl-2-prop-2-ynyloxybenzene afforded 1-[4-(2,6-diisopropylphenoxymethyl)-[1,2,3]triazol-1-yl]-1,2-diphenyl-butan-2-ol 14 as a white solid. Yield: 265 mg (55%), m.p.: 146.5–147.4 °C. IR (ATR, cm−1): 3432, 3058, 3032, 2963, 2868, 1740, 1448, 1191, 1036, 698. 1H NMR: (300 MHz, CDCl3) δ = 7.87 (s, 1H), 7.23–6.92 (m, 10H), 7.03 (s, 3H), 5.74 (s, 1H), 4.89 (s, 2H), 3.73 (s, 1H), 3.29 (p, J = 6.9 Hz, 2H), 2.00 (dq, J = 14.6, 7.4 Hz, 1H), 1.58–1.41 (m, 1H), 1.12 (d, J = 6.9 Hz, 12H), 0.60 (t, J = 7.3 Hz, 3H). 13C NMR: (75 MHz, CDCl3) δ = 152.86, 144.37, 141.90, 141.03, 135.11, 129.01, 128.13, 128.06, 127.86, 127.09, 125.99, 125.10, 124.39, 124.20, 80.04, 74.13, 68.11, 32.19, 26.66, 24.13, 7.60. HRMS (DART, [M+1]+) m/z calcd. For C31H38N3O2: 484.2964; found: 484.2955.
- 1-(4-Morpholin-4-ylmethyl-[1,2,3]triazol-1-yl)-1,2-diphenyl-butan-2-ol (15)
1-Azido-1,2-diphenyl-butan-2-ol and 4-prop-2-ynyl-morpholine afforded 1-(4-morpholin-4-ylmethyl-[1,2,3]triazol-1-yl)-1,2-diphenyl-butan-2-ol 15 as a white solid. Yield: 251 mg (64%), m.p.: 152.7–153.3 °C. IR (ATR, cm−1): 3194, 3144, 3066, 3030, 2966, 2930, 2894, 2816, 1741, 1663, 1604, 1558, 1495, 1450, 1210, 1114, 1003, 697. 1H NMR: (300 MHz, CDCl3) δ = 7.78 (s, 1H), 7.33–6.98 (m, 10H), 5.76 (s, 1H), 3.83 (s, 1H), 3.71 (q, J = 3.4 Hz, 6H), 2.57–2.48 (m, 4H), 2.06 (dq, J = 14.6, 7.4 Hz, 1H), 1.59–1.40 (m, 1H), 0.67 (t, J = 7.3 Hz, 3H). 13C NMR: (75 MHz, CDCl3) δ = 143.36, 141.05, 135.14, 128.95, 128.06, 127.98, 127.82, 127.01, 125.95, 124.60, 79.95, 73.94, 66.75, 53.62, 53.36, 32.04, 7.56. HRMS (DART, [M+1]+) m/z calcd. For C23H29N4O2: 393.2291; found: 393.2955.
- 1,2-Diphenyl-1-(4-phenyl-[1,2,3]triazol-1-yl)-hexan-2-ol (16)
1-Azido-1,2-diphenyl-hexan-2-ol and phenylacetylene afforded 1,2-diphenyl-1-(4-phenyl-[1,2,3]triazol-1-yl)-hexan-2-ol 16 as a white solid. Yield: 138 mg (35%), m.p.: 184.4–185.2 °C. IR (ATR, cm−1): 3463, 3142, 3030, 2959, 2930, 2863, 1955, 1882, 1768, 1448, 1159, 761, 697. 1H NMR: (300 MHz, CDCl3) δ = 8.00 (d, J = 2.5 Hz, 1H), 7.84–7.75 (m, 2H), 7.35 (t, J = 7.4 Hz, 2H), 7.31–6.95 (m, 11H), 5.74 (d, J = 2.7 Hz, 1H), 3.76 (d, J = 4.7 Hz, 1H), 2.00 (ddd, J = 16.7, 12.4, 4.5 Hz, 1H), 1.48 (dd, J = 13.6, 4.2 Hz, 1H), 1.24–1.00 (m, 1H), 1.06 (s, 1H), 0.81 (d, J = 14.3 Hz, 1H), 0.66 (t, J = 7.1 Hz, 3H). 13C NMR: (75 MHz, CDCl3) δ = 143.36, 141.05, 135.14, 128.95, 128.06, 127.98, 127.82, 127.01, 125.95, 124.60, 79.95, 73.94, 66.75, 53.62, 53.36, 32.04, 7.56. HRMS (DART, [M+1]+) m/z calcd. For C26H28N3O: 398.2232; found: 398.2223.
- 1-(4-Cyclopropyl-[1,2,3]triazol-1-yl)-1,2-diphenyl-hexan-2-ol (17)
1-Azido-1,2-diphenyl-hexan-2-ol and cyclopropylacetylene afforded 1-(4-cyclopropyl-[1,2,3]triazol-1-yl)-1,2-diphenyl-hexan-2-ol 17 as a white solid. Yield: 218 mg (60%), m.p.: 169–169.5 °C. IR (ATR, cm−1): 3177, 3092, 2956, 2869, 1743, 1564, 1449, 1214, 1054, 732, 699. 1H NMR: (300 MHz, CDCl3) δ 7.42 (s, 1H), 7.23–6.91 (m, 10H), 5.57 (s, 1H), 4.00 (s, 1H), 2.00–1.81 (m, 2H), 1.42 (ddd, J = 13.8, 11.7, 4.1 Hz, 1H), 1.28–0.96 (m, 3H), 0.94–0.73 (m, 5H), 0.66 (t, J = 7.2 Hz, 3H). 13C NMR: (75 MHz, CDCl3) δ = 149.66, 141.59, 135.29, 128.87, 128.01, 127.85, 127.70, 126.91, 125.86, 121.78, 79.72, 73.92, 39.12, 25.48, 22.83, 13.95, 7.90, 6.70. HRMS (DART, [M+1]+) m/z calcd. For C23H28N3O: 362.2232; found: 362.2222.
- 2-[1-(2-Hydroxy-1,2-diphenyl-hexyl)-[1,2,3]triazol-4-ylmethyl]-isoindole-1,3-dione (18)
1-Azido-1,2-diphenyl-hexan-2-ol and 2-prop-2-ynyl-isoindole-1,3-dione afforded 2-[1-(2-hydroxy-1,2-diphenyl-hexyl)-1H-[1,2,3]triazol-4-ylmethyl]-isoindole-1,3-dione 18 as a white solid. Yield: 341 mg (71%), m.p.: 187.8–188.5 °C. IR (ATR, cm−1): 3462, 3398, 3292, 3147, 3027, 2949, 2864, 1769, 1705, 1428, 1398, 1093, 935, 699. 1H NMR: (300 MHz, CDCl3) δ 7.82 (s, 1H), 7.82–7.70 (m, 2H), 7.70–7.56 (m, 2H), 7.21–6.90 (m, 10H), 5.62 (s, 1H), 4.94 (s, 2H), 1.92 (ddd, J = 13.7, 11.6, 4.5 Hz, 1H), 1.35 (ddd, J = 13.7, 11.7, 4.1 Hz, 1H), 1.24–1.04 (m, 1H), 1.09–0.91 (m, 1H), 1.02 (s, 1H), 0.87–0.69 (m, 1H), 0.76 (s, 1H), 0.61 (t, J = 7.2 Hz, 3H). 13C NMR: (75 MHz, CDCl3) δ = 167.67, 167.00, 142.27, 141.43, 134.91, 134.26, 134.12, 132.05, 128.95, 128.02, 127.95, 127.75, 126.94, 125.81, 124.81, 123.59, 123.48, 79.66, 74.20, 39.00, 33.02, 25.42, 22.75, 13.89. HRMS (DART, [M+1]+) m/z calcd. For C29H29N4O3: 481.2240; found: 481.2229.
- 1-[4-(2,6-Diisopropy-phenoxymethyl)-[1,2,3]triazol-1-yl]-1,2-diphenyl-hexan-2-ol (19)
1-Azido-1,2-diphenyl-hexan-2-ol and 1,3-diisopropyl-2-prop-2-ynyloxybenzene afforded 1-[4-(2,6-diisopropylphenoxymethyl)-[1,2,3]triazol-1-yl]-1,2-diphenyl-hexan-2-ol 14 as a white solid. Yield: 376 mg (73%), m.p.: 151–151.5 °C. IR (ATR, cm−1): 3380, 3167, 3027, 2962, 2868, 1741, 1449, 1172, 977, 757, 698. 1H NMR: (300 MHz, CDCl3) δ 7.94 (s, 1H), 7.34–6.99 (m, 13H), 5.79 (s, 1H), 4.98 (s, 2H), 3.82 (s, 1H), 3.38 (p, J = 6.9 Hz, 2H), 2.07 (ddd, J = 13.8, 11.6, 4.5 Hz, 1H), 1.55 (ddd, J = 13.8, 11.7, 4.1 Hz, 1H), 1.32–1.09 (m, 15H), 1.04–0.82 (m, 1H), 0.75 (t, J = 7.2 Hz, 3H). 13C NMR: (75 MHz, CDCl3) δ = 152.85, 144.38, 141.89, 141.49, 135.09, 128.95, 128.10, 128.02, 127.83, 127.03, 125.84, 125.22, 125.07, 124.30, 124.18, 124.11, 79.76, 74.20, 68.15, 39.17, 26.64, 25.50, 24.10, 22.84, 13.96. HRMS (DART, [M+1]+) m/z calcd. For C33H42N3O2: 512.3277; found: 512.3269.
- 1-(4-Morpholin-4-ylmethyl-[1,2,3]triazol-1-yl)-1,2-diphenyl-hexan-2-ol (20)
1-Azido-1,2-diphenyl-hexan-2-ol and 4-prop-2-ynyl-morpholine afforded 1-(4-morpholin-4-ylmethyl-[1,2,3]triazol-1-yl)-1,2-diphenyl-hexan-2-oll 20 as a white solid. Yield: 260 mg (62%), m.p.: 123–123.6 °C. IR (ATR, cm−1): 3243, 3030, 2958, 2932, 2864, 2818, 1451, 1115, 1003, 699. 1H NMR: (300 MHz, CDCl3) δ 7.74 (s, 1H), 7.23–6.93 (m, 10H), 5.70 (s, 1H), 3.62 (q, J = 7.1 Hz, 7H), 2.43 (t, J = 4.5 Hz, 4H), 1.96 (ddd, J = 13.6, 11.5, 4.5 Hz, 1H), 1.45–1.25 (m, 1H), 1.06 (hept, J = 6.9 Hz, 4H), 0.64 (t, J = 7.1 Hz, 4H). 13C NMR: (75 MHz, CDCl3) δ = 141.52, 135.05, 128.93, 128.06, 127.97, 127.79, 127.00, 125.81, 79.68, 74.08, 66.83, 53.72, 53.43, 39.02, 25.38, 22.81, 13.87. HRMS (DART, [M+1]+) m/z calcd. For C25H33N4O2: 421.2604; found: 421.2595.
- 1,2,3-Triphenyl-1-(4-phenyl-[1,2,3]triazol-1-yl)-propan-2-ol (21)
1-Azido-1,2,3-triphenyl-propan-2-ol and phenylacetylene afforded 1,2,3-triphenyl-1-(4-phenyl-[1,2,3]triazol-1-yl)-propan-2-ol 21 as a white solid. Yield: 186 mg (43%), m.p.: 228–228.5 °C. IR (ATR, cm−1): 3457, 3444, 3061, 3029, 2929, 1948, 1880, 1742, 1449, 1361, 1156, 759. 1H NMR: (300 MHz, DMSO-d6) δ = 8.82 (s, 1H), 8.00–7.91 (m, 2H), 7.56–7.42 (m, 4H), 7.42–7.30 (m, 3H), 7.19–6.96 (m, 9H), 6.89 (dd, J = 6.7, 3.0 Hz, 2H), 6.48 (s, 1H), 5.78 (s, 1H), 3.38 (d, J = 13.9 Hz, 1H), 2.77 (d, J = 13.8 Hz, 1H). 13C NMR: (75 MHz, DMSO-d6) δ = 146.72, 142.58, 136.97, 136.61, 131.26, 131.02, 130.15, 129.33, 128.35, 128.25, 128.10, 127.73, 127.69, 126.92, 126.85, 126.32, 125.81, 122.45, 79.62, 79.53, 72.24, 46.25, 40.84, 40.56, 40.28, 40.00, 39.72, 39.45, 39.17. HRMS (DART, [M+1]+) m/z calcd. For C29H26N3O: 432.2076; found: 432.2071.
- 1-(4-Cyclopropyl-[1,2,3]triazol-1-yl)-1,2,3-triphenyl-propan-2-ol (22)
1-Azido-1,2,3-triphenyl-propan-2-ol and cyclopropylacetylene afforded 1-(4-cyclopropyl-[1,2,3]triazol-1-yl)-1,2,3-triphenyl-propan-2-ol 22 as a white solid. Yield: 233 mg (59%), m.p.: 168.2–169.0 °C. IR (ATR, cm−1): 3433, 3146, 3060, 3028, 3000, 2933, 1743, 1450, 1362, 1161, 1046, 727, 696. 1H NMR: (300 MHz, CDCl3) δ = 7.74 (s, 1H), 7.20–7.11 (m, 4H), 7.02 (dq, J = 24.4, 6.3 Hz, 9H), 6.67–6.59 (m, 2H), 6.01 (s, 1H), 3.47 (s, 1H), 3.31 (d, J = 13.2 Hz, 1H), 2.69 (d, J = 13.4 Hz, 1H), 0.93–0.80 (m, 4H). 13C NMR: (75 MHz, CDCl3) δ = 148.95, 140.34, 134.20, 133.60, 129.60, 129.43, 128.32, 128.06, 126.84, 126.75, 126.73, 126.11, 125.89, 125.65, 125.35, 124.92, 120.12, 78.29, 71.29, 44.62, 6.76, 6.68, 5.67. HRMS (DART, [M+1]+) m/z calcd. For C26H26N3O: 396.2076; found: 396.2065.
- 2-[1-(2-Hydroxy-1,2,3-triphenyl-propyl)-[1,2,3]triazol-4-ylmethyl]-isoindole-1,3-dione (23)
1-Azido-1,2,3-triphenyl-propan-2-ol and 2-prop-2-ynyl-isoindole-1,3-dione afforded 2-[1-(2-hydroxy-1,2,3-triphenyl-propyl)-[1,2,3]triazol-4-ylmethyl]-isoindole-1,3-dione 23 as a white solid. Yield: 244 mg (44%), m.p.: 224.9–225.5 °C. IR (ATR, cm−1): 3435, 3149, 3010, 2947, 2862, 1715, 1612, 1515, 1370, 1255, 1096, 765. 1H NMR: (300 MHz, CDCl3) δ = 8.19 (s, 1H), 7.88 (dd, J = 5.4, 3.1 Hz, 2H), 7.72 (dd, J = 5.5, 3.0 Hz, 2H), 7.31–7.01 (m, 13H), 6.68 (dt, J = 6.6, 1.6 Hz, 2H), 6.13 (s, 1H), 5.07 (s, 1H), 4.07–3.91 (m, 1H), 3.82–3.59 (m, 1H), 3.38 (d, J = 13.6 Hz, 1H), 2.67 (d, J = 13.6 Hz, 1H). 13C NMR: (75 MHz, CDCl3) δ = 177.69, 167.69, 142.61, 141.46, 135.01, 134.49, 134.09, 132.12, 130.60, 129.29, 128.06, 128.03, 127.96, 127.94, 127.12, 126.88, 126.07, 124.42, 123.48, 79.34, 72.68, 45.64, 33.16, 29.69, 29.55, 29.52, 27.79, 23.92, 23.84, 23.81, 23.48, 22.18, 6.15. HRMS (DART, [M+1]+) m/z calcd. For C32H27N4O3: 515.2083; found: 515.2069.
- 1-[4-(2,6-Diisopropyl-phenoxymethyl)-[1,2,3]triazol-1-yl]-1,2,3-triphenyl-propan-2-ol (24)
1-Azido-1,2,3-triphenyl-propan-2-ol and 1,3-diisopropyl-2-prop-2-ynyloxybenzene afforded 1-[4-(2,6-diisopropyl-phenoxymethyl)-[1,2,3]triazol-1-yl]-1,2,3-triphenyl-propan-2-ol 24 as a white solid. Yield: 225 mg (41%), m.p.: 167.1–167.6 °C. IR (ATR, cm−1): 3250, 3173, 3061, 3030, 2962, 2926, 2867, 1494, 1447, 1357, 1253, 1180, 1102, 1052, 968, 699. 1H NMR: (300 MHz, CDCl3) δ = 8.22 (s, 1H), 7.36–7.00 (m, 16H), 6.75–6.67 (m, 2H), 6.21 (s, 1H), 5.27 (s, 1H), 5.02 (s, 2H), 3.53–3.34 (m, 3H), 3.28–3.22 (m, 1H), 1.31–1.20 (m, 13H). 13C NMR: (75 MHz, CDCl3) δ = 153.02, 144.88, 141.91, 141.49, 135.19, 134.49, 130.62, 129.33, 128.16, 128.11, 128.04, 127.21, 127.02, 126.10, 124.18, 123.85, 79.41, 72.70, 68.31, 45.81, 26.70, 24.12, 24.08. HRMS (DART, [M+1]+) m/z calcd. For C36H40N3O2: 546.3121; found: 546.3112.
- 1-(4-Morpholin-4-ylmethyl-[1,2,3]triazol-1-yl)-1,2,3-triphenyl-propan-2-ol (25)
1-Azido-1,2,3-triphenyl-propan-2-ol and 4-prop-2-ynyl-morpholine afforded 1-(4-morpholin-4-ylmethyl-[1,2,3]triazol-1-yl)-1,2,3-triphenyl-propan-2-ol 25 as a white solid. Yield: 218 mg (48%), m.p.: 160.2–161.8 °C. IR (ATR, cm−1): 3420, 3338, 3121, 3036, 3029, 2957, 2826, 1741, 1659, 1495, 1450, 1217, 1113, 698. 1H NMR: (300 MHz, CDCl3) δ = 8.06 (s, 1H), 7.35–7.00 (m, 13H), 6.74–6.64 (m, 2H), 6.17 (s, 1H), 3.77–3.67 (m, 6H), 3.43 (d, J = 13.5 Hz, 1H), 3.28 (s, 1H), 2.68 (d, J = 13.6 Hz, 1H), 2.60–2.51 (m, 4H). 13C NMR: (75 MHz, CDCl3) δ = 141.09, 134.80, 134.13, 130.20, 128.93, 127.76, 127.69, 127.64, 127.62, 126.80, 126.62, 125.69, 123.86, 79.02, 72.19, 66.43, 53.40, 53.02, 45.34, 31.22, 22.29, 13.76. HRMS (DART, [M+1]+) m/z calcd. For C28H31N4O2: 455.2447; found: 455.2439.
- 1-Cyclohexyl-1,2-diphenyl-2-(4-phenyl-[1,2,3]triazol-1-yl)-ethanol (26)
2-Azido-1-cyclohexyl-1,2-diphenyl-ethanol and phenylacetylene afforded 1-cyclohexyl-1,2-diphenyl-2-(4-phenyl-[1,2,3]triazol-1-yl)-ethanol 26 as a white solid. Yield: 260 mg (61%), m.p.: 237–237.5 °C. IR (ATR, cm−1): 3514, 3404, 3149, 3028, 2933, 2852, 1741, 1718, 1445, 1355, 1031, 759, 692. 1H NMR: (300 MHz, DMSO-d6) δ = 8.42 (s, 1H), 7.74–7.63 (m, 2H), 7.52–7.42 (m, 2H), 7.34–7.27 (m, 2H), 7.27–7.16 (m, 2H), 7.16–7.04 (m, 1H), 6.98 (t, J = 7.5 Hz, 2H), 6.94–6.78 (m, 4H), 6.59 (s, 1H), 5.39 (s, 1H), 2.19–0.45 (m, 11H). 13C NMR: (75 MHz, DMSO-d6) δ = 195.29, 146.42, 141.50, 137.93, 131.30, 130.72, 130.06, 129.97, 129.28, 128.27, 127.92, 127.44, 126.73, 125.72, 122.02, 80.98, 67.68, 46.52, 28.39, 26.94, 26.60, 26.34. HRMS (DART, [M+1]+) m/z calcd. For C28H30N3O: 424.2389; found: 424.2379.
- 1-Cyclohexyl-2-(4-cyclopropyl-[1,2,3]triazol-1-yl)-1,2-diphenyl-ethanol (27)
2-Azido-1-cyclohexyl-1,2-diphenyl-ethanol and cyclopropylacetylene afforded 1-cyclohexyl-2-(4-cyclopropyl-[1,2,3]triazol-1-yl)-1,2-diphenyl-ethanol 27 as a white solid. Yield: 166 mg (43%), m.p.: 190.2–192 °C. IR (ATR, cm−1): 3396, 3087, 3031, 2932, 2854, 1740, 1557, 1495, 1449, 1330, 1233, 1040, 701. 1H NMR: (300 MHz, CDCl3) δ = 7.54 (s, 1H), 7.44–7.33 (m, 2H), 7.33–7.17 (m, 4H), 7.21–7.10 (m, 1H), 7.15–6.99 (m, 3H), 6.34 (s, 1H), 3.79 (s, 1H), 1.95 (ddd, J = 13.4, 6.7, 4.2 Hz, 2H), 1.89–1.67 (m, 2H), 1.65 (s, 1H), 1.55 (dd, J = 27.8, 12.3 Hz, 2H), 1.39 (tt, J = 11.7, 2.7 Hz, 1H), 1.29–0.76 (m, 7H), 0.47–0.28 (m, 1H). 13C NMR: (75 MHz, CDCl3) δ = 148.89, 139.13, 135.15, 128.69, 127.16, 127.06, 126.65, 126.10, 126.02, 125.84, 120.64, 80.43, 67.82, 46.56, 28.03, 26.20, 25.82, 25.51, 25.35, 7.13, 7.09, 6.00, -0.75. HRMS (DART, [M+1]+) m/z calcd. For C25H30N3O: 388.2389; found: 388.2379.
- 2-[1-(2-Cyclohexyl-2-hydroxy-1,2-diphenyl-ethyl)-[1,2,3]triazol-4-ylmethyl]-isoindole-1,3-dione (28)
2-Azido-1-cyclohexyl-1,2-diphenyl-ethanol and 2-prop-2-ynyl-isoindole-1,3-dione afforded 2-[1-(2-cyclohexyl-2-hydroxy-1,2-diphenyl-ethyl)-[1,2,3]triazol-4-ylmethyl]-isoindole-1,3-dione 28 as a white solid. Yield: 324 mg (64%), m.p.: 218–218.3 °C. IR (ATR, cm−1): 3555, 3464, 3292, 2930, 2854, 1770, 1708, 1608, 1393, 1329, 1097, 939, 698. 1H NMR: (300 MHz, CDCl3) δ = 7.96 (s, 1H), 7.84 (dd, J = 5.5, 3.0 Hz, 2H), 7.70 (dd, J = 5.5, 3.1 Hz, 2H), 7.46–7.32 (m, 2H), 7.32–7.18 (m, 4H), 7.18–7.10 (m, 1H), 7.06 (p, J = 3.6 Hz, 3H), 6.40 (s, 1H), 5.08–4.95 (m, 2H), 2.01–1.89 (m, 1H), 1.81 (s, 1H), 1.65–1.52 (m, 3H), 1.45 (d, J = 11.7 Hz, 1H), 1.30 (tt, J = 11.8, 2.7 Hz, 1H), 1.19–0.76 (m, 4H), 0.36 (qd, J = 12.8, 3.4 Hz, 1H). 13C NMR: (75 MHz, CDCl3) δ = 191.68, 167.64, 142.10, 139.76, 135.48, 134.08, 132.08, 129.54, 129.06, 127.99, 127.43, 126.91, 126.58, 124.59, 123.46, 81.17, 68.94, 47.17, 33.09, 28.70, 26.93, 26.45, 26.19, 26.07. HRMS (DART, [M+1]+) m/z calcd. For C31H31N4O3: 507.2396; found: 507.2390.
- 1-Cyclohexyl-2-[4-(2,6-diisopropyl-phenoxymethyl)-[1,2,3]triazol-1-yl]-1,2-diphenyl-ethanol (29)
2-Azido-1-cyclohexyl-1,2-diphenyl-ethanol and 1,3-diisopropyl-2-prop-2-ynyloxybenzene afforded 1-cyclohexyl-2-[4-(2,6-diisopropyl-phenoxymethyl)-[1,2,3]triazol-1-yl]-1,2-diphenyl-ethanol 29 as a white solid. Yield: 163 mg (30%), m.p.: 144–144.3 °C. IR (ATR, cm−1): 3260, 3064, 3029, 2959, 2928, 2864, 1741, 1600, 1448, 1317, 1177, 996, 703. 1H NMR: (300 MHz, CDCl3) δ = 8.00 (s, 1H), 7.44–7.27 (m, 4H), 7.31–7.14 (m, 3H), 7.19–7.05 (m, 3H), 6.50 (s, 1H), 4.99 (d, J = 2.6 Hz, 2H), 3.53 (s, 1H), 3.37 (hept, J = 6.9 Hz, 2H), 2.05 (d, J = 11.5 Hz, 1H), 1.91–1.80 (m, 1H), 1.76–1.52 (m, 2H), 1.50 (s, 1H), 1.47–1.16 (m, 15H), 1.19–0.92 (m, 2H), 0.97–0.80 (m, 3H), 0.42 (qd, J = 12.7, 3.4 Hz, 1H). 13C NMR: (75 MHz, CDCl3) δ = 153.01, 144.39, 141.89, 139.79, 135.70, 129.56, 128.09, 128.01, 127.50, 126.98, 126.62, 125.02, 124.03, 81.22, 68.83, 68.24, 47.20, 28.74, 26.95, 26.68, 26.53, 26.26, 26.09, 25.30, 24.07, 24.04, 22.67. HRMS (DART, [M+1]+) m/z calcd. For C35H44N3O2: 538.3434; found: 538.3426.
- 1-Cyclohexyl-2-(4-morpholin-4-ylmethyl-[1,2,3]triazol-1-yl)-1,2-diphenyl-ethanol (30)
2-Azido-1-cyclohexyl-1,2-diphenyl-ethanol and 4-prop-2-ynyl-morpholine afforded 1-cyclohexyl-2-(4-morpholin-4-ylmethyl-[1,2,3]triazol-1-yl)-1,2-diphenyl-ethanol 30 as a white solid. Yield: 215 mg (48%), m.p.: 169.5–170.3 °C. IR (ATR, cm−1): 3480, 3109, 3033, 2930, 2853, 2813, 1673, 1496, 1449, 1116, 1052, 1002, 861, 702. 1H NMR: (300 MHz, CDCl3) δ = 7.92 (s, 1H), 7.39–7.05 (m, 10H), 6.45 (s, 1H), 3.72 (d, J = 5.5 Hz, 7H), 2.56 (d, J = 6.0 Hz, 4H), 1.97 (d, J = 11.7 Hz, 1H), 1.85 (s, 1H), 1.72–1.55 (m, 2H), 1.54–1.40 (m, 2H), 1.39–0.80 (m, 4H), 0.39 (qd, J = 12.6, 3.3 Hz, 1H). 13C NMR: (75 MHz, CDCl3) δ = 200.81, 139.87, 135.63, 129.48, 128.03, 127.96, 127.50, 126.96, 126.58, 124.65, 81.19, 68.86, 66.64, 60.09, 53.31, 47.28, 28.65, 26.94, 26.50, 26.36, 14.13, 12.03. HRMS (DART, [M+1]+) m/z calcd. For C27H35N4O2: 447.2760; found: 447.2850.
- 1,2-Bis-(4-methoxyphenyl)-1-(4-phenyl-[1,2,3]triazol-1-yl)-butan-2-ol (31)
1-Azido-1,2-bis-(4-methoxyphenyl)-butan-2-ol and phenylacetylene afforded 1,2-bis-(4-methoxy-phenyl)-1-(4-phenyl-[1,2,3]triazol-1-yl)-butan-2-ol 31 as a white solid. Yield: 262 mg (61%), m.p.: 171–171.6 °C. IR (ATR, cm−1): 3451, 3159, 2966, 2935, 2833, 1741, 1611, 1512, 1253, 1176, 1031, 797. 1H NMR: (300 MHz, DMSO-d6) δ = 8.68 (s, 1H), 7.96–7.88 (m, 2H), 7.53–7.40 (m, 4H), 7.40–7.27 (m, 3H), 6.82–6.74 (m, 2H), 6.74–6.65 (m, 2H), 6.17 (s, 1H), 5.55 (s, 1H), 3.65 (d, J = 14.6 Hz, 6H), 1.95 (dq, J = 14.5, 7.2 Hz, 1H), 1.33 (dt, J = 14.1, 7.1 Hz, 1H), 0.55 (t, J = 7.2 Hz, 3H). 13C NMR: (75 MHz, DMSO-d6) δ = 158.87, 157.92, 146.52, 131.43, 131.33, 129.55, 129.30, 128.25, 127.76, 125.70, 121.82, 113.56, 113.37, 79.06, 72.01, 55.30, 55.26, 33.05, 8.13. HRMS (DART, [M+1]+) m/z calcd. For C26H28N3O3: 430.2131; found: 430.2123.
- 1-(4-Cyclopropyl-[1,2,3]triazol-1-yl)-1,2-bis-(4-methoxyphenyl)-butan-2-ol (32)
1-Azido-1,2-bis-(4-methoxyphenyl)-butan-2-ol and cyclopropylacetylene afforded 1-(4-cyclopropyl-[1,2,3]triazol-1-yl)-1,2-bis-(4-methoxyphenyl)-butan-2-ol 32 as a white solid. Yield: 259 mg (66%), m.p.: 136.5–138 °C. IR (ATR, cm−1): 3211, 3012, 2957, 2837, 1741, 1610, 1511, 1462, 1245, 1177, 1029, 797. 1H NMR: (300 MHz, CDCl3) δ 7.40 (s, 1H), 7.13–7.02 (m, 2H), 7.02–6.91 (m, 2H), 6.73–6.63 (m, 2H), 6.59–6.48 (m, 2H), 5.52 (s, 1H), 3.81 (s, 1H), 3.68 (s, 3H), 3.61 (s, 3H), 1.97–1.84 (m, 1H), 1.84 (dd, J = 8.1, 5.0 Hz, 1H), 1.40 (dq, J = 14.3, 7.2 Hz, 1H), 0.93–0.72 (m, 4H), 0.59 (t, J = 7.3 Hz, 3H). 13C NMR: (75 MHz, CDCl3) δ = 159.03, 158.33, 149.58, 133.31, 130.14, 127.70, 127.19, 121.59, 113.33, 113.12, 79.77, 77.49, 77.27, 77.07, 76.64, 73.33, 55.14, 55.09, 32.08, 7.87, 7.85, 7.58, 6.67. HRMS (DART, [M+1]+) m/z calcd. For C23H28N3O3: 394.2131; found: 394.2121.
- 2-{1-[2-Hydroxy-1,2-bis-(4-methoxy-phenyl)-butyl]-[1,2,3]triazol-4-ylmethyl}-isoindole-1,3-dione (33)
1-Azido-1,2-bis-(4-methoxyphenyl)-butan-2-ol and 2-prop-2-ynyl-isoindole-1,3-dione afforded 2-{1-[2-hydroxy-1,2-bis-(4-methoxy-phenyl)-butyl]-[1,2,3]triazol-4-ylmethyl}-isoindole-1,3-dione 33 as a white solid. Yield: 230 mg (45%), m.p.: 148.2–149 °C. IR (ATR, cm−1): 3522, 3465, 3396, 3138, 2970, 2936, 1714, 1613, 1514, 1256, 1032, 716. 1H NMR: (300 MHz, CDCl3) δ 7.83–7.72 (m, 3H), 7.69–7.57 (m, 2H), 7.10–7.02 (m, 2H), 7.01–6.94 (m, 2H), 6.67 (d, J = 8.6 Hz, 2H), 6.52 (d, J = 8.5 Hz, 2H), 5.56 (s, 1H), 4.92 (s, 2H), 3.90–3.29 (m, 7H), 1.87 (dq, J = 14.6, 7.3 Hz, 1H), 1.35 (dq, J = 14.3, 7.2 Hz, 1H), 0.56 (t, J = 7.2 Hz, 3H). 13C NMR: (75 MHz, CDCl3) δ = 167.67, 159.09, 158.35, 134.11, 133.13, 132.05, 130.23, 127.35, 127.15, 124.56, 123.48, 113.35, 113.17, 79.71, 73.65, 55.13, 55.08, 33.01, 32.03, 7.53. HRMS (DART, [M+1]+) m/z calcd. For C29H28N4O5: 513.2138; found: 513.2132.
- 1-[4-(2,6-Diisopropylphenoxymethyl)-[1,2,3]triazol-1-yl]-1,2-bis-(4-methoxyphenyl)-butan-2-ol (34)
1-Azido-1,2-bis-(4-methoxyphenyl)-butan-2-ol and 1,3-diisopropyl-2-prop-2-ynyloxybenzene afforded 1-[4-(2,6-diisopropyl-phenoxymethyl)-[1,2,3]triazol-1-yl]-1,2-bis-(4-methoxy-phenyl)-butan-2-ol 34 as a white solid. Yield: 298 mg (55%), m.p.: 128.5–129 °C. IR (ATR, cm−1): 3474, 3149, 3013, 2962, 2932, 2838, 1612, 1513, 1462, 1250, 1178, 1036, 803. 1H NMR: (300 MHz, CDCl3) δ 7.83 (s, 1H), 7.15–7.06 (m, 2H), 7.06–6.97 (m, 5H), 6.75–6.65 (m, 2H), 6.62–6.51 (m, 2H), 5.66 (s, 1H), 4.89 (s, 2H), 3.68 (s, 3H), 3.62 (s, 3H), 3.30 (hept, J = 6.8 Hz, 2H), 1.94 (dq, J = 14.6, 7.4 Hz, 1H), 1.45 (dq, J = 14.3, 7.2 Hz, 1H), 1.14 (d, J = 6.9 Hz, 12H), 0.61 (t, J = 7.2 Hz, 3H). 13C NMR: (75 MHz, CDCl3) δ = 159.17, 158.43, 152.83, 144.23, 141.89, 133.18, 130.25, 127.18, 125.06, 124.17, 124.10, 113.43, 113.24, 79.81, 73.66, 68.08, 55.16, 55.13, 32.17, 26.63, 24.09, 7.59. HRMS (DART, [M+1]+) m/z calcd. For C33H42N3O4: 544.3175; found: 544.3168.
- 1-(4-Morpholin-4-ylmethyl-[1,2,3]triazol-1-yl)- 1,2-bis-(4-methoxyphenyl)-butan-2-ol (35)
1-Azido-1,2-bis-(4-methoxyphenyl)-butan-2-ol and 4-prop-2-ynyl-morpholine afforded 1-(4-morpholin-4-ylmethyl-[1,2,3]triazol-1-yl)-1,2-bis-(4-methoxyphenyl)-butan-2-ol 35 as a white solid. Yield: 271 mg (60%), m.p.: 198.5–199 °C. IR (ATR, cm−1): 3211, 3012, 2957, 2837, 1741, 1610, 1511, 1462, 1245, 1177, 1029, 797. 1H NMR: (300 MHz, CDCl3) δ 7.75 (s, 1H), 7.21–7.05 (m, 4H), 6.82–6.73 (m, 2H), 6.69–6.60 (m, 2H), 5.69 (s, 1H), 3.80–3.68 (m, 13H), 2.76 (s, 1H), 2.53 (t, J = 4.6 Hz, 4H), 2.00 (td, J = 13.3, 6.0 Hz, 1H), 1.46 (dq, J = 14.3, 7.2 Hz, 1H), 0.68 (t, J = 7.3 Hz, 3H). 13C NMR: (75 MHz, CDCl3) δ = 159.11, 158.38, 143.22, 133.22, 130.21, 127.17, 124.44, 113.37, 113.20, 79.74, 73.49, 66.74, 55.14, 55.10, 53.65, 53.34, 32.00, 7.57. HRMS (DART, [M+1]+) m/z calcd. For C25H35N4O4: 453.2502; found: 453.2492.
- 1,2-Bis-(4-methoxyphenyl)-1-(4-phenyl-[1,2,3]triazol-1-yl)-hexan-2-ol (36)
1-Azido-1,2-bis-(4-methoxyphenyl)-hexan-2-ol and phenylacetylene afforded 1,2-bis-(4-methoxy-phenyl)-1-(4-phenyl-[1,2,3]triazol-1-yl)-hexan-2-ol 36 as a white solid. Yield: 228 mg (50%), m.p.: 163.8–163.5 °C. IR (ATR, cm−1): 3196, 2950, 2930, 2834, 1610, 1512, 1457, 1250, 1174, 1033, 760. 1H NMR: (300 MHz, CDCl3) δ 7.97 (s, 1H), 7.77 (d, J = 7.5 Hz, 2H), 7.34 (t, J = 7.5 Hz, 2H), 7.29–7.20 (m, 1H), 7.11 (d, J = 8.3 Hz, 2H), 7.02 (d, J = 8.3 Hz, 2H), 6.70 (d, J = 8.3 Hz, 2H), 6.55 (d, J = 8.3 Hz, 2H), 5.67 (s, 1H), 3.68 (s, 3H), 3.60 (s, 3H), 1.92 (t, J = 12.8 Hz, 1H), 1.43 (td, J = 12.7, 3.9 Hz, 1H), 1.20–0.99 (m, 4H), 0.82 (d, J = 13.7 Hz, 1H), 0.65 (t, J = 7.1 Hz, 3H). 13C NMR: (75 MHz, CDCl3) δ = 159.13, 158.38, 147.22, 133.76, 132.51, 130.37, 130.21, 128.89, 128.30, 127.53, 127.07, 125.75, 121.32, 114.22, 113.68, 113.42, 113.26, 79.57, 73.64, 55.16, 55.11, 39.27, 25.52, 22.81, 13.97. HRMS (DART, [M+1]+) m/z calcd. For C28H32N3O3: 458.2444; found: 458.2436.
- 1-(4-Cyclopropyl-[1,2,3]triazol-1-yl)-1,2-bis-(4-methoxyphenyl)-hexan-2-ol (37)
1-Azido-1,2-bis-(4-methoxyphenyl)-hexan-2-ol and cyclopropylacetylene afforded 1-(4-cyclopropyl-[1,2,3]triazol-1-yl)-1,2-bis-(4-methoxy-phenyl)-hexan-2-ol 37 as a white solid. Yield: 160 mg (38%), m.p.: 176–176.7 °C. IR (ATR, cm−1): 3211, 3170, 2955, 2931, 2838, 1741, 1610, 1511, 1447, 1249, 1177, 1029, 801. 1H NMR: (300 MHz, CDCl3) δ 7.38 (s, 1H), 7.07 (dd, J = 9.0, 2.4 Hz, 2H), 6.98–6.89 (m, 2H), 6.73–6.63 (m, 2H), 6.58–6.49 (m, 2H), 5.50 (s, 1H), 3.89–3.82 (m, 1H), 3.68 (d, J = 1.0 Hz, 3H), 3.61 (d, J = 0.9 Hz, 3H), 1.94–1.79 (m, 1H), 1.36 (td, J = 12.6, 3.9 Hz, 1H), 1.20–0.97 (m, 3H), 0.94–0.73 (m, 5H), 0.66 (t, J = 7.1 Hz, 3H). 13C NMR: (75 MHz, CDCl3) δ = 159.02, 158.29, 149.59, 133.81, 130.11, 129.90, 127.70, 127.05, 121.56, 114.05, 113.32, 113.10, 79.50, 77.48, 77.06, 76.63, 73.44, 55.25, 55.08, 39.13, 25.51, 22.83, 13.96, 7.86, 6.69. HRMS (DART, [M+1]+) m/z calcd. For C25H32N3O3: 422.2444; found: 422.2435.
- 2-{1-[2-Hydroxy-1,2-bis-(4-methoxyphenyl)-hexyl]-[1,2,3]triazol-4-ylmethyl}-isoindole-1,3-dione (38)
1-Azido-1,2-bis-(4-methoxyphenyl)-hexan-2-ol and 2-prop-2-ynyl-isoindole-1,3-dione afforded 1-(4-cyclopropyl-[1,2,3]triazol-1-yl)-1,2-bis-(4-methoxy-phenyl)-hexan-2-ol 38 as a white solid. Yield: 226 mg (42%), m.p.: 100–101.5 °C. IR (ATR, cm−1): 3435, 3149, 3010, 2947, 2862, 1715, 1612, 1515, 1370, 1255, 1096, 765. 1H NMR: (300 MHz, CDCl3) δ 7.87–7.74 (m, 1H), 7.75 (q, J = 3.2 Hz, 2H), 7.70–7.56 (m, 2H), 7.10–7.00 (m, 2H), 6.94 (d, J = 8.5 Hz, 2H), 6.72–6.62 (m, 2H), 6.51 (d, J = 8.5 Hz, 2H), 5.54 (s, 1H), 4.93 (s, 2H), 3.67 (s, 3H), 3.59 (s, 3H), 1.93–1.72 (m, 1H), 1.29 (td, J = 12.6, 3.8 Hz, 1H), 1.21–0.93 (m, 4H), 0.81 (s, 1H), 0.62 (t, J = 7.1 Hz, 3H). 13C NMR: (75 MHz, CDCl3) δ = 190.17, 167.65, 159.07, 158.32, 134.09, 133.63, 132.06, 130.20, 127.30, 127.02, 125.48, 123.47, 113.34, 113.15, 79.45, 73.76, 55.08, 39.04, 33.04, 25.46, 22.76, 13.91. HRMS (DART, [M+1]+) m/z calcd. For C31H33N4O5: 541.2451; found: 541.2443.
- 1-[4-(2,6-Diisopropy-phenoxymethyl)-[1,2,3]triazol-1-yl]-1,2-bis-(4-methoxyphenyl)-hexan-2-ol (39)
1-Azido-1,2-bis-(4-methoxyphenyl)-hexan-2-ol and 1,3-diisopropyl-2-prop-2-ynyloxybenzene afforded 1-[4-(2,6-diisopropylphenoxymethyl)-[1,2,3]triazol-1-yl]-1,2-bis-(4-methoxy-phenyl)-hexan-2-ol 39 as a white solid. Yield: 226 mg (46%), m.p.: 120.8–121.5 °C. IR (ATR, cm−1): 3466, 3145, 3013, 2962, 2939, 1741, 1612, 1513, 1459, 1250, 1180, 1036, 806. 1H NMR: (300 MHz, CDCl3) δ 8.19–7.67 (m, 1H), 7.23–7.05 (m, 7H), 6.80 (d, J = 8.0 Hz, 2H), 6.67 (d, J = 7.6 Hz, 2H), 5.96–5.63 (m, 1H), 5.18–4.69 (m, 2H), 3.85–3.65 (m, 7H), 3.42 (s, 2H), 2.05 (d, J = 12.2 Hz, 1H), 1.26 (d, J = 4.3 Hz, 16H), 0.95 (s, 1H), 0.79 (t, J = 6.8 Hz, 3H). 13C NMR: (75 MHz, CDCl3) δ = 159.14, 158.35, 152.81, 141.89, 133.71, 130.64, 127.49, 126.57, 125.49, 124.59, 123.69, 114.00, 113.53, 112.79, 79.48, 55.10, 26.31, 24.21, 24.00, 22.85. HRMS (DART, [M+1]+) m/z calcd. For C35H46N3O4: 572.3488; found: 572.3483.
- 1,2-Bis-(4-methoxyphenyl)-1-(4-morpholin-4-ylmethyl-[1,2,3]triazol-1-yl)-hexan-2-ol (40)
1-Azido-1,2-bis-(4-methoxyphenyl)-hexan-2-ol and 4-prop-2-ynyl-morpholine afforded 1,2-bis-(4-methoxy-phenyl)-1-(4-morpholin-4-ylmethyl-[1,2,3]triazol-1-yl)-hexan-2-ol 40 as a white solid. Yield: 197 mg (41%), m.p.: 110.8–111.5 °C. IR (ATR, cm−1): 3258, 3004, 2951, 2863, 1741, 1610, 1512, 1243, 1115, 1034, 800. 1H NMR: (300 MHz, CDCl3) δ 7.75 (s, 1H), 7.16 (dd, J = 9.3, 2.5 Hz, 2H), 7.07 (dd, J = 9.3, 2.6 Hz, 2H), 6.82–6.72 (m, 2H), 6.72–6.58 (m, 2H), 5.67 (s, 1H), 3.89–3.68 (m, 13H), 2.57–2.48 (m, 4H), 1.97 (ddd, J = 13.7, 11.4, 4.3 Hz, 1H), 1.46–1.30 (m, 1H), 1.17 (m, 2H), 0.99–0.83 (m, 1H), 0.74 (t, J = 7.1 Hz, 3H). 13C NMR: (75 MHz, CDCl3) δ = 190.43, 159.10, 158.36, 143.35, 133.70, 130.19, 127.42, 127.03, 124.40, 113.36, 113.18, 79.48, 73.60, 66.77, 55.36, 53.38, 39.02, 25.42, 22.82, 13.89. HRMS (DART, [M+1]+) m/z calcd. For C27H37N4O4: 481.2815; found: 481.2806.
- 1,2-Bis-(4-methoxyphenyl)-3-phenyl-1-(4-phenyl-[1,2,3]triazol-1-yl)-propan-2-ol (41)
1-Azido-1,2-bis-(4-methoxyphenyl)-3-phenyl-propan-2-ol and phenylacetylene afforded 1,2-bis-(4-methoxy-phenyl)-3-phenyl-1-(4-phenyl-[1,2,3]triazol-1-yl)-propan-2-ol 41 as a white solid. Yield: 227 mg (46%), m.p.: 183–183.7 °C. IR (ATR, cm−1): 3457, 3144, 3061, 3029, 2929, 1880, 1742, 1493, 1449, 1361, 1329, 1156, 759, 693. 1H NMR: (300 MHz, DMSO-d6) δ = 8.75 (s, 1H), 7.99–7.89 (m, 2H), 7.52–7.41 (m, 4H), 7.40–7.30 (m, 1H), 7.30–7.21 (m, 2H), 7.03 (dd, J = 5.2, 1.9 Hz, 3H), 6.89 (dt, J = 6.2, 2.2 Hz, 2H), 6.76–6.62 (m, 4H), 6.37 (s, 1H), 5.65 (s, 1H), 3.63 (d, J = 2.7 Hz, 6H), 3.31 (d, J = 13.8 Hz, 1H), 2.70 (d, J = 13.8 Hz, 1H). 13C NMR: (75 MHz, DMSO-d6) δ = 156.45, 155.43, 144.22, 134.34, 132.21, 128.96, 128.84, 128.74, 128.61, 126.88, 126.39, 125.88, 125.66, 125.29, 123.85, 123.33, 111.18, 110.54, 76.96, 69.26, 52.87, 52.76, 44.00, 38.35, 38.08, 37.80, 37.52, 37.24, 36.96, 36.69. HRMS (DART, [M+1]+) m/z calcd. For C31H30N3O3: 492.2287; found: 492.2282.
- 1-(4-Cyclopropyl-[1,2,3]triazol-1-yl)-1,2-bis-(4-methoxyphenyl)-3-phenyl-propan-2-ol (42)
1-Azido-1,2-bis-(4-methoxyphenyl)-3-phenyl-propan-2-ol and cyclopropylacetylene afforded 1-(4-cyclopropyl-[1,2,3]triazol-1-yl)-1,2-bis-(4-methoxy-phenyl)-3-phenyl-propan-2-ol 42 as a white solid. Yield: 227 mg (50%), m.p.: 176.9–177.5 °C. IR (ATR, cm−1): 3418, 3151, 3079, 3013, 2952, 2835, 1741, 1612, 1512, 1460, 1251, 1179, 1030, 806, 541. 1H NMR: (300 MHz, CDCl3) δ = 7.62 (s, 1H), 7.15–7.07 (m, 2H), 7.07–6.93 (m, 5H), 6.68–6.58 (m, 4H), 6.58–6.48 (m, 2H), 5.90 (s, 1H), 3.77–3.63 (m, 1H), 3.64 (s, 3H), 3.58 (s, 3H), 3.31 (s, 1H), 3.25 (d, J = 13.5 Hz, 1H), 2.63 (d, J = 13.5 Hz, 1H), 1.91 (tt, J = 8.1, 5.1 Hz, 1H), 0.95–0.76 (m, 4H). 13C NMR: (75 MHz, CDCl3) δ = 159.02, 158.35, 135.00, 133.75, 130.67, 130.48, 128.01, 127.82, 127.29, 126.76, 113.29, 113.23, 78.95, 72.02, 55.09, 55.06, 45.87, 7.94, 7.85, 6.85. HRMS (DART, [M+1]+) m/z calcd. For C28H30N3O3: 456.2287; found: 456.2281.
- 2-{1-[2-Hydroxy-1,2-bis-(4-methoxyphenyl)-3-phenyl-propyl]-[1,2,3]triazol-4-ylmethyl}-isoindole-1,3-dione (43)
1-Azido-1,2-bis-(4-methoxyphenyl)-3-phenyl-propan-2-ol and 2-prop-2-ynyl-isoindole-1,3-dione afforded 2-{1-[2-hydroxy-1,2-bis-(4-methoxy-phenyl)-3-phenyl-propyl]-1H-[1,2,3]triazol-4-ylmethyl}-isoindole-1,3-dione 43 as a white solid. Yield: 229 mg (40%), m.p.: 192.3–193.9 °C. IR (ATR, cm−1): 3466, 3144, 3061, 3024, 2951, 2836, 1706, 1612, 1514, 1398, 1254, 1182, 1097, 1028, 712. 1H NMR: (300 MHz, DMSO-d6) δ = 8.32 (s, 1H), 7.95–7.80 (m, 4H), 7.39–7.28 (m, 2H), 7.26–7.15 (m, 2H), 7.00 (dd, J = 4.8, 1.9 Hz, 3H), 6.80 (dd, J = 6.6, 3.0 Hz, 2H), 6.66 (t, J = 8.6 Hz, 4H), 6.29 (s, 1H), 5.51 (s, 1H), 4.89 (s, 2H), 3.61 (d, J = 2.3 Hz, 6H), 3.18 (d, J = 13.6 Hz, 1H), 2.56 (d, J = 13.7 Hz, 1H). 13C NMR: (75 MHz, DMSO-d6) δ = 167.89, 158.87, 157.89, 142.39, 136.69, 135.04, 134.59, 132.07, 131.24, 131.03, 129.14, 128.05, 127.70, 126.25, 124.35, 123.70, 113.57, 112.95, 79.39, 71.45, 55.31, 55.20, 46.30, 40.79, 40.51, 40.23, 39.96, 39.68, 39.40, 39.12, 33.49, 30.89. HRMS (DART, [M+1]+) m/z calcd. For C34H31N4O5: 575.2294; found: 575.2087.
- 1-[4-(2,6-Diisopropylphenoxymethyl)-[1,2,3]triazol-1-yl]-1,2-bis-(4-methoxy-phenyl)-3-phenyl-propan-2-ol (44)
1-Azido-1,2-bis-(4-methoxyphenyl)-3-phenyl-propan-2-ol and 1,3-diisopropyl-2-prop-2-ynyloxybenzene afforded 1-[4-(2,6-diisopropyl-phenoxymethyl)-[1,2,3]triazol-1-yl]-1,2-bis-(4-methoxy-phenyl)-3-phenyl-propan-2-ol 44 as a white solid. Yield: 229 mg (38%), m.p.: 148.2–148.9 °C. IR (ATR, cm−1): 3388, 3139, 3064, 2960, 2908, 2868, 2837, 1740, 1612, 1514, 1457, 1251, 1182, 1035, 806, 542. 1H NMR: (300 MHz, CDCl3) δ = 8.23 (s, 1H), 7.29 (d, J = 8.5 Hz, 2H), 7.22–7.07 (m, 8H), 6.80–6.72 (m, 4H), 6.68 (d, J = 8.2 Hz, 2H), 6.18 (s, 1H), 5.05 (s, 2H), 3.77 (s, 3H), 3.72 (s, 3H), 3.44 (t, J = 9.7 Hz, 3H), 3.16 (s, 1H), 2.77 (d, J = 13.2 Hz, 1H), 1.28 (d, J = 5.7 Hz, 12H). 13C NMR: (75 MHz, CDCl3) δ = 159.16, 158.46, 153.02, 141.92, 134.69, 133.71, 130.68, 130.60, 128.14, 127.29, 126.95, 125.03, 124.17, 113.41, 113.34, 55.12, 55.11, 45.86, 26.69, 24.14, 24.10. HRMS (DART, [M+1]+) m/z calcd. For C38H44N3O4: 606.3332; found: 606.3327.
- 1,2-Bis-(4-methoxyphenyl)-1-(4-morpholin-4-ylmethyl-[1,2,3]triazol-1-yl)-3-phenyl-propan-2-ol (45)
1-Azido-1,2-bis-(4-methoxyphenyl)-3-phenyl-propan-2-ol and 4-prop-2-ynyl-morpholine afforded 1,2-bis-(4-methoxyphenyl)-1-(4-morpholin-4-ylmethyl-[1,2,3]triazol-1-yl)-3-phenyl-propan-2-ol 45 as a white solid. Yield: 262 mg (51%), m.p.: 161.5–162.4 °C. IR (ATR, cm−1): 3437, 3143, 2926, 2835, 1741, 1611, 1513, 1456, 1254, 1178, 1118, 1029, 752, 701, 547. 1H NMR: (300 MHz, CDCl3) δ 7.93 (s, 1H), 7.16 (d, J = 8.6 Hz, 3H), 7.08–6.94 (m, 6H), 6.67–6.51 (m, 7H), 5.99 (s, 1H), 3.66 (d, J = 6.0 Hz, 10H), 3.60 (s, 3H), 3.29 (d, J = 13.5 Hz, 1H), 3.07 (s, 1H), 2.56 (d, J = 13.5 Hz, 1H). 13C NMR: (75 MHz, CDCl3) δ = 159.09, 158.41, 134.73, 133.67, 131.21, 130.62, 130.55, 130.19, 130.03, 129.79, 128.45, 128.33, 127.26, 126.91, 125.91, 124.09, 114.23, 114.11, 113.65, 113.38, 113.29, 112.82, 112.52, 79.21, 72.12, 66.80, 65.85, 55.10, 55.07, 53.80, 53.37, 45.74, 37.94, 15.29. HRMS (DART, [M+1]+) m/z calcd. For C30H35N4O4: 515.2658; found: 515.2656.
- 1,2-Bis-(4-methoxyphenyl)-5-methyl-1-(4-phenyl-[1,2,3]triazol-1-yl)-hexan-2-ol (46)
1-Azido-1,2-bis-(4-methoxyphenyl)-5-methyl-hexan-2-ol and phenylacetylene afforded 1,2-bis-(4-methoxyphenyl)-5-methyl-1-(4-phenyl-[1,2,3]triazol-1-yl)-hexan-2-ol 46 as a white solid. Yield: 296 mg (63%), m.p.: 175–175.6 °C. IR (ATR, cm−1): 3249, 3151, 3001, 2952, 2867, 1741, 1611, 1510, 1461, 1365, 1248, 1177, 1036, 766, 561. 1H NMR: (300 MHz, CDCl3) δ 8.13–8.04 (m, 1H), 7.94–7.80 (m, 2H), 7.44 (ddd, J = 7.6, 6.5, 1.3 Hz, 2H), 7.43–7.29 (m, 1H), 7.27–7.15 (m, 2H), 7.18–7.06 (m, 2H), 6.92–6.74 (m, 2H), 6.72–6.60 (m, 2H), 5.77 (s, 1H), 3.91–3.67 (m, 7H), 2.06 (td, J = 13.0, 4.3 Hz, 1H), 1.62–1.46 (m, 1H), 1.45–1.12 (m, 2H), 1.24 (s, 1H), 0.74 (d, J = 6.4 Hz, 7H). 13C NMR: (75 MHz, CDCl3) δ = 159.13, 158.37, 147.20, 133.71, 130.18, 128.88, 128.29, 127.56, 127.09, 125.75, 121.28, 113.41, 113.25, 79.59, 73.71, 55.15, 55.11, 37.27, 32.19, 28.08, 22.82, 22.18. HRMS (DART, [M+1]+) m/z calcd. For C29H34N3O3: 472.2600; found: 472.2589.
- 1-(4-Cyclopropyl-[1,2,3]triazol-1-yl)-1,2-bis-(4-methoxyphenyl)-5-methyl-hexan-2-ol (47)
1-Azido-1,2-bis-(4-methoxyphenyl)-5-methyl-hexan-2-ol and cyclopropylacetylene afforded 1-(4-cyclopropyl-[1,2,3]triazol-1-yl)-1,2-bis-(4-methoxy-phenyl)-5-methyl-hexan-2-ol 47 as a white solid. Yield: 200 mg (46%), m.p.: 155–155.7 °C. IR (ATR, cm−1): 3264, 3178, 2958, 2837, 1741, 1611, 1511, 1249, 1178, 1029, 801, 552. 1H NMR: (300 MHz, CDCl3) δ 7.38 (s, 1H), 7.11–7.00 (m, 2H), 6.99–6.88 (m, 2H), 6.73–6.62 (m, 2H), 6.58–6.47 (m, 2H), 5.50 (s, 1H), 3.89–3.82 (m, 1H), 3.68 (s, 3H), 3.61 (s, 3H), 1.97–1.80 (m, 1H), 1.44–1.17 (m, 2H), 1.21–1.02 (m, 1H), 0.94–0.73 (m, 4H), 0.78–0.61 (m, 7H). 13C NMR: (75 MHz, CDCl3) δ = 159.01, 158.28, 149.60, 133.76, 130.09, 127.72, 127.07, 121.55, 113.31, 113.09, 79.51, 73.50, 55.13, 55.08, 37.13, 32.19, 28.08, 22.81, 22.19, 7.87, 7.83. HRMS (DART, [M+1]+) m/z calcd. For C26H34N3O3: 436.2600; found: 436.2594.
- 2-{1-[2-Hydroxy-1,2-bis-(4-methoxyphenyl)-5-methyl-hexyl]-[1,2,3]triazol-4-ylmethyl}-isoindole-1,3-dione (48)
1-Azido-1,2-bis-(4-methoxyphenyl)-5-methyl-hexan-2-ol and 2-prop-2-ynyl-isoindole-1,3-dione afforded 2-{1-[2-Hydroxy-1,2-bis-(4-methoxyphenyl)-5-methyl-hexyl]-[1,2,3]triazol-4-ylmethyl}-isoindole-1,3-dione 48 as a white solid. Yield: 288 mg (52%), m.p.: 173.3–174.4 °C. IR (ATR, cm−1): 3462, 3145, 2954, 2868, 2837, 1703, 1613, 1515, 1398, 1254, 1097, 764, 715, 521. 1H NMR: (300 MHz, CDCl3) δ 7.90–7.79 (m, 3H), 7.72 (dt, J = 5.4, 3.3 Hz, 2H), 7.17–6.98 (m, 5H), 6.81–6.70 (m, 2H), 6.66–6.55 (m, 2H), 5.63 (s, 1H), 5.02 (s, 3H), 3.72 (d, J = 22.6 Hz, 6H), 1.95 (td, J = 13.0, 4.3 Hz, 1H), 1.34 (qd, J = 12.6, 5.3 Hz, 2H), 1.14 (tt, J = 12.4, 5.1 Hz, 1H), 0.69 (dd, J = 6.6, 1.6 Hz, 8H). 13C NMR: (75 MHz, CDCl3) δ = 167.63, 159.08, 158.32, 134.08, 133.57, 132.05, 130.19, 127.28, 127.03, 124.62, 123.46, 113.34, 113.15, 79.47, 73.80, 55.12, 55.08, 37.02, 33.02, 32.12, 28.00, 22.70, 22.17. HRMS (DART, [M+1]+) m/z calcd. For C32H35N4O5: 555.2607; found: 555.2597.
- 1-[4-(2,6-Diisopropylphenoxymethyl)-[1,2,3]triazol-1-yl]-1,2-bis-(4-methoxyphenyl)-5-methyl-hexan-2-ol (49)
1-Azido-1,2-bis-(4-methoxyphenyl)-5-methyl-hexan-2-ol and 1,3-diisopropyl-2-prop-2-ynyloxybenzene afforded 1-[4-(2,6-diisopropylphenoxymethyl)-[1,2,3]triazol-1-yl]-1,2-bis-(4-methoxy-phenyl)-5-methyl-hexan-2-ol 49 as a pale- yellow oil. Yield: 288 mg (55%), colorless oil. IR (ATR, cm−1): 3453, 2958, 2866, 1741, 1608, 1512, 1447, 1249, 1177, 1119, 1033, 802. 1H NMR: (300 MHz, CDCl3) δ 7.84 (s, 1H), 7.13–7.04 (m, 2H), 7.05 (s, 3H), 7.03–6.95 (m, 2H), 6.74–6.65 (m, 2H), 6.61–6.52 (m, 2H), 5.64 (s, 1H), 4.90 (s, 2H), 3.69 (s, 3H), 3.63 (s, 3H), 3.30 (hept, J = 6.9 Hz, 2H), 1.94 (td, J = 13.5, 4.7 Hz, 1H), 1.47–1.35 (m, 1H), 1.33–1.22 (m, 1H), 1.15 (d, J = 6.9 Hz, 13H), 0.80–0.68 (m, 1H), 0.73 (s, 1H), 0.67 (dd, J = 6.6, 2.9 Hz, 6H). 13C NMR: (75 MHz, CDCl3) δ = 193.49, 159.17, 158.40, 152.88, 144.28, 141.87, 133.65, 130.20, 127.49, 127.06, 125.03, 124.15, 124.11, 113.41, 113.23, 79.55, 73.83, 68.14, 55.14, 55.12, 37.22, 32.22, 28.08, 26.64, 24.06, 22.80, 22.19, 1.85. HRMS (DART, [M+1]+) m/z calcd. For C36H48N3O4: 586.3645; found: 586.3636.
- 1,2-Bis-(4-methoxyphenyl)-5-methyl-1-(4-morpholin-4-ylmethyl-[1,2,3]triazol-1-yl)-hexan-2-ol (50)
1-Azido-1,2-bis-(4-methoxyphenyl)-5-methyl-hexan-2-ol and 4-prop-2-ynyl-morpholine afforded 1,2-bis-(4-methoxyphenyl)-5-methyl-1-(4-morpholin-4-ylmethyl-[1,2,3]triazol-1-yl)-hexan-2-ol 50 as a white solid. Yield: 296 mg (60%), 153.5–154. IR (ATR, cm−1): 3364, 2951, 2838, 1741, 1609, 1512, 1457, 1246, 1177, 1030, 803. 1H NMR: (300 MHz, CDCl3) δ 7.79 (s, 1H), 7.16–7.02 (m, 4H), 6.78–6.70 (m, 2H), 6.65–6.57 (m, 2H), 5.68 (s, 1H), 3.74 (s, 3H), 3.68 (s, 2H), 3.64 (dd, J = 3.9, 2.0 Hz, 6H), 3.18 (s, 4H), 2.00–1.84 (m, 2H), 1.30 (dq, J = 13.6, 5.0 Hz, 2H), 1.12 (td, J = 12.7, 6.0 Hz, 1H), 0.73–0.65 (m, 6H). 13C NMR: (75 MHz, CDCl3) δ = 177.70, 159.11, 158.33, 142.91, 133.72, 130.24, 127.45, 127.03, 124.53, 113.36, 113.22, 79.46, 73.59, 70.57, 66.90, 66.57, 61.62, 55.12, 53.22, 37.07, 32.05, 28.07, 22.55, 22.22. HRMS (DART, [M+1]+) m/z calcd. For C28H39N4O4: 495.2971; found: 495.2957.
3.3. Tumor Cell Lines and Culture Medium
The compounds were screened in vitro against human cancer cell lines: HCT-15 (human colorectal adenocarcinoma), MCF-7 (human mammary adenocarcinoma), K562 (human chronic myelogenous leukemia), U251 (human glioblastoma), PC-3 (human pro- static adenocarcinoma) which were supplied by National Cancer Institute (Bethesda, MD, USA); SKLU-1 (human lung adenocarcinoma) from National Institute of Cancerology, Mexico, and COS-7, adherent monkey kidney fibroblasts (ATTC).
The human tumor cytotoxicity was determined using the protein-binding dye sulforhodamine B (SRB) in microculture assay to measure cell growth, as described in the protocols established by the NCI [15]. The cell lines were cultured in RPMI-1640 medium supplemented with 10% fetal bovine serum, 2 mM L-glutamine, Penicillin-Streptomycin solution 100x (Gibco, Waltham, MA, USA) and 1% non-essential amino acids (Gibco®). They were maintained at 37 °C in humidified atmosphere with 5% CO2. The viability of the cells used in the experiments exceed 95% as determined with trypan blue.
Cytotoxicity Assay
Cytotoxicity after treatment of the tumors cells and normal cell with the test compounds was determined using the protein-binding dye sulforhodamine B (SRB) in microculture assay to measure cell growth as described in the reference [49]. The cells were removed from the tissue culture flasks by treatment with trypsin and diluted with fresh media. Of this cell suspension, 100 μL containing 5000–10,000 cell per well, were pipetted into 96 well microtiter plates (Costar) and the material was incubated at 37 °C for 24 h in a 5% CO2 atmosphere. Each cell line is deposited by triplicate and subsequently, 100 μL of a solution of the compound obtained by diluting the stocks were added to each well. The cultures were exposed for 48 h to the compound at concentrations 25 μM. After the incubation period, cells were fixed to the plastic substratum by the addition of 50 μL of cold 50% aqueous trichloroacetic acid. The plates were incubated at 4 °C for 1 h, washed with tap H2O, and air-dried. The trichloroacetic-acid-fixed cells were stained by the addition of 0.4% SRB. Free SRB solution was the removed by washing with 1% aqueous acetic acid. The plates were the air-dried, and the bound dye was solubilized by the addition of 10 mM un-buffered Tris base (100 μL). The plates were placed on a shaker for 10 min, and the absorption was determined at 515 nm using an ELISA plate reader (Bio-Tex Instruments, Bio-Tek Instruments, Winooski, VT, USA).
3.4. In Vitro Antimicrobial Activity
The antimicrobial activity of compounds 11–50 was screened using a reference strain from American Type Culture Collection, Staphylococcus aureus ATCC 29213, and a clinical isolate of Candida albicans obtained from a urine culture of a 34-year-old female patient. This strain was provided by the Laboratorio de Especialidades Clínicas de San Jerónimo (Tacámbaro, Michoacán, Mexico). Identification was performed using an automated identification system VITEK® 2, ensuring high taxonomic reliability. All isolates were maintained on Sabouraud Dextrose Agar (SDA) at 37 °C for 24 h prior to biological assays.
4. Conclusions
A library of 1,2-diphenyl-2-[1,2,3]triazol-1-yl-ethanol derivatives was obtained from CuAAC reaction as the key reaction. Triazoles 11 and 30 have crystal structures that reveal significant O-H···N interactions, which are involved in the crystal form in these compounds. These interactions play a key role in shaping each structure. Synthesized 1,2-diphenyl-2-[1,2,3]triazol-1-yl-ethanol derivatives exhibited significant cytotoxic activity, which is enhanced by the presence of longer alkyl chains, providing an important starting point for future research. In addition, some of these compounds presented interesting selective inhibition activity against C. albicans and S. aureus strains. Worthy of mention is the use of benzoin as a privileged structure, which facilitated the preparation of target molecules, providing an alternative source for the synthesis and development of new therapeutic options in the field of medicinal chemistry, so these new molecules as well as the synthetic protocols will find widespread applications.
Supplementary Materials
The following supporting information can be downloaded at: https://www.mdpi.com/article/10.3390/molecules31010170/s1.
Author Contributions
Conceptualization, E.C.-Y.; methodology, N.M.-R., M.V.-S., L.T.-C., M.T.R.-A. and J.A.O.-G.; software, E.C.-Y. and D.M.-O.; validation, M.V.-S., M.A.G.-E., C.A.G.-G. and D.C.-B.; formal analysis, M.V.-S., L.T.-C., D.M.-O. and D.M.-M.; investigation, E.C.-Y., N.M.-R.; resources, E.C.-Y., M.A.G.-E., C.A.G.-G., D.C.-B. and D.M.-M.; data curation, M.T.R.-A., L.T.-C., D.M.-O., D.M.-M. and J.A.O.-G.; writing—original draft preparation, E.C.-Y., N.M.-R. and J.A.O.-G.; writing—review and editing, E.C.-Y.; visualization, E.C.-Y.; supervision, E.C.-Y. and M.A.G.-E.; project administration, E.C.-Y.; funding acquisition, E.C.-Y., M.A.G.-E., C.A.G.-G. and D.C.-B. All authors have read and agreed to the published version of the manuscript.
Funding
This research was funded by SECIHTI-CONAHCYT-Mexico, fellowship for N.M.-R. (CVU: 1318908) and M.V.-S. (CVU: 593548).
Data Availability Statement
The raw data supporting the conclusions of this article will be made available by the authors on request.
Acknowledgments
Financial support from CONAHCYT is gratefully acknowledged. The authors would like to thank N. Zavala, A. Nuñez, and M. C. Martínez for the technical support.
Conflicts of Interest
The authors declare no conflicts of interest.
References
- DeSimone, R.W.; Currie, K.S.; Mitchell, S.A.; Darrow, J.W.; Pippin, D.A. Privileged Structures: Applications in Drug Discovery. Comb. Chem. High Throughput Screen. 2004, 7, 473–493. [Google Scholar] [CrossRef]
- Zhuang, C.; Zhang, W.; Sheng, C.; Zhang, W.; Xing, C.; Miao, Z. Chalcone: A Privileged Structure in Medicinal Chemistry. Chem. Rev. 2017, 117, 7762–7810. [Google Scholar] [CrossRef]
- Zhang, L.; Zhang, G.; Xu, S.; Song, Y. Recent advances of quinones as a privileged structure in drug discovery. Eur. J. Med. Chem. 2021, 223, 113632. [Google Scholar] [CrossRef]
- Sun, D.J.; Zhu, L.J.; Zhao, Y.-Q.; Zhen, Y.-Q.; Zhang, L.; Lin, C.C.; Chen, L.-X. Diarylheptanoid: A privileged structure in drug discovery. Fitoterapia 2020, 142, 104490. [Google Scholar] [CrossRef]
- Mir, R.H.; Mohi-ud-din, R.; Mir, P.A.; Shah, A.J.; Banday, N.; Sabreen, S.; Maqbool, M.; Jan, R.; Shafi, N.; Masoodi, M.H. Curcumin as a privileged scaffold molecule for various biological targets in drug development. In Studies in Natural Products Chemistry; Atta-ur-Rahman, Ed.; Elsevier: Amsterdam, The Netherlands, 2022; Volume 73, pp. 405–434. [Google Scholar]
- Kourounakis, A.P.; Xanthopoulos, D.; Tzara, A. Morpholine as a privileged structure: A review on the medicinal chemistry and pharmacological activity of morpholine containing bioactive molecules. Med. Res. Rev. 2020, 40, 709–752. [Google Scholar] [CrossRef]
- Yayli, N.; Gözde Kılıç, G.; Kahriman, N.; Kanbolat, S.; Bozdeveci, A.; Karaoglu, S.A.; Aliyazıcıoğlu, R.; Sellitepe, H.E.; Doğan, I.S.; Aydin, A.; et al. Synthesis, biological evaluation (antioxidant, antimicrobial, enzyme inhibition, and cytotoxic) and molecular docking study of hydroxy methoxy benzoin/benzil analogous. Bioorg. Chem. 2021, 115, 105183. [Google Scholar] [CrossRef]
- Yayli, Y.; Kiliç, G.; Çelik, G.; Kahriman, N.; Kanbolat, S.; Bozdeveci, A.; Karaoğlu, S.A.; Aliyazicioğlu, R.; Sellitepe, H.E.; Doğan, I.S.; et al. Synthesis of hydroxy benzoin/benzil analogs and investigation of their antioxidant, antimicrobial, enzyme inhibition, and cytotoxic activities. Turk. J. Chem. 2021, 45, 788–804. [Google Scholar] [CrossRef]
- Yayli, N.; Kahriman, N.; Kılıç, G.; Serdaroğlu, V.; Aliyazıcıoğlu, R.; Sellitepe, H.E.; Karaoğlu, S.A.; Yılmaz, G.T. Molecular docking, synthesis and biological evaluation (enzyme inhibition, antimicrobial and antioxidant) of methoxy benzoin/benzil/stilbenoid derivatives. Org. Commun. 2022, 15, 129–147. [Google Scholar]
- Sabbah, D.A.; Al-Tarawneh, F.; Talib, W.H.; Sweidan, K.; Bardaweel, S.K.; Al-Shalabi, E.; Zhong, H.A.; Sheikha, G.A.; Khalaf, R.A.; Mubarak, M.S. Benzoin Schiff Bases: Design, Synthesis, and Biological Evaluation as Potential Antitumor Agents. Med. Chem. 2018, 14, 695–708. [Google Scholar] [CrossRef]
- Sabbah, D.A.; Ibrahim, A.H.; Talib, W.H.; Alqaisi, K.M.; Sweidan, K.; Bardaweel, S.K.; Sheikha, G.A.; Zhong, H.A.; Al-Shalabi, E.; Khalaf, R.A.; et al. Ligand-Based Drug Design: Synthesis and Biological Evaluation of Substituted Benzoin Derivatives as Potential Antitumor Agents. Med. Chem. 2019, 15, 417–429. [Google Scholar] [CrossRef]
- Mousset, C.; Giraud, A.; Provot, O.; Hamze, A.; Bignon, J.; Liu, J.M.; Thoret, S.; Dubois, J.; Brion, J.D.; Alami, A. Synthesis and antitumor activity of benzils related to combretastatin A-4. Bioorg. Med. Chem. Lett. 2008, 18, 3266–3271. [Google Scholar] [CrossRef]
- Tamaddon, F.; Amirpoor, F. Improved Catalyst-Free Synthesis of Pyrrole Derivatives in Aqueous Media. Synlett 2013, 24, 1791–1794. [Google Scholar] [CrossRef]
- Tamaddon, F.; Farahi, M. A New Three-Component Reaction Catalyzed by Silica Sulfuric Acid: Synthesis of Tetrasubstituted Pyrroles. Synlett 2012, 23, 1379–1383. [Google Scholar] [CrossRef]
- Goel, A.; Agarwal, N.; Singh, F.V.; Sharon, A.; Tiwari, P.; Dixit, M.; Pratap, R.; Srivastava, A.K.; Maulik, P.R.; Rama, V.J. Antihyperglycemic activity of 2-methyl-3,4,5-triaryl-1H-pyrroles in SLM and STZ models. Bioorg. Med. Chem. Lett. 2004, 14, 1089–1092. [Google Scholar] [CrossRef]
- Liang, F.F.; Liu, K.X.; Zhao, C.; Shang, Z.H.; Kong, H.-M.; Yin, Y.Q.; Zhu, Y.P.; Sun, Y.Y.; Yao, J.W. Convergent Domino Cyclization: Oxidative [3+1+1] Annulation for One-Pot Synthesis of 2-Quinoline-4,5-diaryloxazoles from Methyl Azaarenes, Benzoins and NH4OAc. Eur. J. Org. Chem. 2021, 2021, 998–1002. [Google Scholar] [CrossRef]
- Sabbah, D.A.; Saada, M.; Khalaf, R.A.; Bardaweel, S.; Sweidan, K.; Al-Qirim, T.; Al-Zughier, A.; Halim, H.A.; Sheikha, G.A. Molecular modeling based approach, synthesis, and cytotoxic activity of novel benzoin derivatives targeting phosphoinostide 3-kinase (PI3Ka). Bioorg. Med. Chem. Lett. 2015, 25, 3120–3124. [Google Scholar] [CrossRef]
- Mostafa, E.A.; Zarie, E.S.; Shalaby, A.S.G.; Basyounia, W.M.; El-Bayouki, K.A.M. An Efficient Catalyst for the Fabrication of Substituted Pyrroles with Specific Nanomorphology as Potential Antimicrobial and Antioxidant Agents. Egypt. J. Chem. 2023, 66, 323–334. [Google Scholar]
- Prasanth, K.N.; Vijayalakshmi, A. Synthesis, characterization, and evaluation of some novel derivatives of Benzoin. Drug Invent. Today 2018, 10, 304–309. [Google Scholar]
- Jesmin, M.; Ali, M.M.; Salahuddin, M.S.; Habib, M.R.; Khanam, J.A. Antimicrobial Activity of Some Schiff Bases Derived from Benzoin, Salicylaldehyde, Aminophenol and 2,4 Dinitrophenyl Hydrazine. Mycobiology 2008, 36, 70–73. [Google Scholar] [CrossRef][Green Version]
- Zakir, H.M.; Jesmin, M.; Ali, S.M.M. Antibacterial Activities of Benzoin Thiosemicarbazone and Its Complexes with Co(II) and Ni(II). Asian J. Med. Pharm. Res. 2016, 6, 32–40. [Google Scholar]
- Chandrasekaran, S. (Ed.) Click Reactions in Organic Synthesis; Wiley-VCH: Wienheim, Germany, 2016. [Google Scholar]
- El-Azab, A.S.; Abdel-Aziz, A.A.M. Click Chemistry and Applications; LAP Lambert Academic Publishing: Saarbrücken, Germany, 2014. [Google Scholar]
- Lahann, J. (Ed.) Click Chemistry for Biotechnology and Materials Science; John Wiley & Sons: Chichester, UK, 2009. [Google Scholar]
- Haroun, M.; Tratrat, C.; Kochkar, H.; Nair, A.B. Recent advances in the development of 1,2,3-triazole-containing derivatives as potential antifungal agents and inhibitors of lanosterol 14 α-demethylase. Curr. Top. Med. Chem. 2021, 21, 462–506. [Google Scholar] [CrossRef]
- Bozorova, H.; Zhao, J.; Aisa, H.A. 1,2,3-Triazole-containing hybrids as leads in medicinal chemistry: A recent overview. Bioorg. Med. Chem. 2019, 27, 3511–3531. [Google Scholar] [CrossRef]
- Bonandi, E.; Christodoulou, M.S.; Fumagalli, G.; Perdicchia, D.; Rastelli, G.; Passarella, D. The 1,2,3-triazole ring as a bioisostere in medicinal chemistry. Drug Discov. Today 2017, 22, 1572–1581. [Google Scholar] [CrossRef]
- Thirumurugan, P.; Matosiuk, D.; Jozwiak, K. Click chemistry for drug development and diverse chemical-biology applications. Chem. Rev. 2013, 113, 4905–4979. [Google Scholar] [CrossRef]
- Zhou, C.H.; Wang, Y. Recent researches in triazole compounds as medicinal drugs. Curr. Med. Chem. 2012, 19, 239–280. [Google Scholar] [CrossRef]
- Agalave, S.G.; Maujan, S.R.; Pore, V.P. Click Chemistry: 1,2,3-Triazoles as Pharmacophores. Chem. Asian J. 2011, 6, 2696–2718. [Google Scholar] [CrossRef]
- Aufort, M.; Herscovici, J.; Bouhours, P.; Moreau, N.; Girard, C. Synthesis and antibiotic activity of a small molecules library of 1,2,3-triazole derivatives. Bioorg. Med. Chem. Lett. 2008, 18, 1195–1198. [Google Scholar] [CrossRef]
- Irfan, M.; Aneja, B.; Yadava, U.; Khan, S.I.; Manzoor, N.; Daniliuc, C.G.; Abid, M. Synthesis, QSAR and anticandidal evaluation of 1,2,3-triazoles derived from naturally bioactive scaffolds. Eur. J. Med. Chem. 2015, 93, 246–254. [Google Scholar] [CrossRef]
- Wang, Y.; Xu, K.; Bai, G.; Huang, L.; Wu, Q.; Pan, W.; Yu, S. Synthesis and antifungal activity of novel triazole compounds containing piperazine moiety. Molecules 2014, 19, 11333–11340. [Google Scholar] [CrossRef]
- Zou, Y.; Zhao, Q.; Liao, J.; Hua, H.; Yu, S.; Chai, X.; Xu, M.; Wu, Q. New triazole derivatives as antifungal agents: Synthesis via click reaction, in vitro evaluation and molecular docking studies. Bioorg. Med. Chem. Lett. 2012, 22, 2959–2962. [Google Scholar] [CrossRef]
- Aher, N.G.; Pore, V.S.; Mishra, N.N.; Kumar, A.; Shukla, P.K.; Sharma, A.; Bhat, M.K. Synthesis and antifungal activity of 1,2,3-triazole containing fluconazole analogues. Bioorg. Med. Chem. Lett. 2009, 19, 759–763. [Google Scholar] [CrossRef]
- Pore, V.S.; Jagtap, M.A.; Agalave, S.G.; Pandey, A.K.; Siddiqi, M.I.; Kumar, V.; Shukla, P.K. Synthesis and antifungal activity of 1,5-disubstituted-1,2,3-triazole containing fluconazole analogues. Med. Chem. Commun. 2012, 3, 484–488. [Google Scholar] [CrossRef]
- Cavalcanti Chipoline, I.; Carvalho da Fonseca, A.A.; Ribeiro Machado da Costa, G.; Pereira de Souza, M.; Won-Held Rabelo, V.; de Queiroz, L.N.; Ferraz de Souza, T.L.; Cardozo Paes de Almeida, E.; Alvarez Abreu, P.; Pontes, B.; et al. Molecular Mechanism of Action of New 1,4-Naphthoquinones tethered to 1,2,3-1H-Triazoles with Cytotoxic and Selective Effect Against Oral Squamous Cell Carcinoma. Bioorg. Chem. 2020, 101, 103984. [Google Scholar] [CrossRef]
- Queiroz, T.M.; Orozco, E.V.M.; Silva, V.R.; Santos, L.S.; Soares, B.P.; Bezerra, D.P.; Porto, A.L.M. Semi-synthesis of β-keto-1,2,3-triazole derivatives from ethinylestradiol and evaluation of the cytotoxic activity. Heliyon 2019, 5, e02408. [Google Scholar] [CrossRef]
- de Andrade, P.; de Fraga Dias, A.; Figueiro, F.; Cidade Torres, F.; Kawano, D.F.; Oliveira Battastini, A.M.; Carvalho, I.; de Paula da Silva, C.H.T.; Campos, J.M. 1,2,3-Triazole tethered 2-mercaptobenzimidazole derivatives: Design, synthesis and molecular assessment toward C6 glioma cell line. Future Med. Chem. 2020, 12, 689–708. [Google Scholar] [CrossRef]
- Jia, Y.; Li, L.; Cao, Y.; Feng, W.; Li, X.; Xue, W.; Shi, H. Discovery of a Novel Benzenesulfonamide Analogue That Inhibits Proliferation and Metastasis Against Ovarian Cancer OVCAR-8 Cells. Drug Des. Dev. Ther. 2020, 14, 207–216. [Google Scholar] [CrossRef]
- Sonego, M.S.; Segatto, N.V.; Damé, L.; Fronza, M.; Gomes, C.B.; Oliveira, T.L.; Kömmling Seixas, F.; Savegnago, L.; Schachtschneider, K.M.; Alves, D.; et al. 7-Chloroquinoline-1,2,3-triazoyl carboxamides induce cell cycle arrest and apoptosis in human bladder carcinoma cells. Investig. New Drug 2020, 38, 1020–1030. [Google Scholar] [CrossRef]
- Vala, D.P.; Miller, A.D.; Atmasidha, A.; Parmar, M.P.; Patel, C.D.; Upadhyay, D.B.; Bhalodiya, S.S.; Gonzalez-Bakker, A.; Khan, A.N.; Nogales, J.; et al. Click-chemistry mediated synthesis of OTBN-1,2,3-Triazole derivatives exhibiting STK33 inhibition with diverse anti-cancer activities. Bioorg. Chem. 2024, 149, 107485. [Google Scholar] [CrossRef]
- Strobykina, I.Y.; Voloshina, A.D.; Andreeva, O.V.; Sapunova, A.S.; Lyubina, A.P.; Amerhanova, S.K.; Belenok, M.G.; Saifina, L.F.; Semenov, V.E.; Kataev, V.E. Synthesis, antimicrobial activity and cytotoxicity of triphenylphosphonium (TPP) conjugates of 1,2,3-triazolyl nucleoside analogues. Bioorg. Chem. 2021, 116, 105328. [Google Scholar] [CrossRef]
- Almazan-Sanchez, L.; Ramírez-Apan, M.T.; Morales-Morales, D.; García-Eleno, M.A.; Cuevas-Yañez, E. 1,2,3-Triazole nilotinib analogues: Synthesis and Cytotoxic activity. Tetrahedron 2024, 167, 134284. [Google Scholar] [CrossRef]
- Ríos-Malváez, Z.G.; Cano-Herrera, M.A.; Dávila-Becerril, J.C.; Mondragón-Solórzano, G.; Ramírez-Apan, M.T.; Morales-Morales, D.; Barroso-Flores, J.; Santillán-Benítez, J.G.; Unnamatla, M.V.B.; García-Eleno, M.A.; et al. Synthesis, characterization and cytotoxic activity evaluation of 4-(1,2,3-triazol-1-yl) salicylic acid derivatives. J. Mol. Struct. 2021, 1225, 129149. [Google Scholar] [CrossRef]
- Zambrano-Huerta, A.; Cifuentes-Castañeda, D.D.; Bautista-Renedo, J.; Mendieta-Zerón, H.; Melgar-Fernández, R.C.; Pavón-Romero, S.; Morales-Rodríguez, M.; Frontana-Uribe, B.A.; González-Rivas, N.; Cuevas-Yañez, E. Synthesis and in vitro biological evaluation of 1,3-bis-(1,2,3-triazol-1-yl)-propan-2-ol derivatives as antifungal compounds fluconazole analogues. Med. Chem. Res. 2019, 28, 571–579. [Google Scholar] [CrossRef]
- Centore, R.; Fusco, S.; Capone, F.; Causa, M. Competition between Polar and Centrosymmetric Packings in Molecular Crystals: Analysis of Actual and Virtual Structures. Cryst. Growth Des. 2016, 16, 2260–2265. [Google Scholar] [CrossRef]
- Steinberg, A.; Ergaz, I.; Toscano, R.A.; Glaser, R. Crystallization of a Racemate Affords a P21 Chiral Crystal Structure: Asymmetric Unit of Two Opposite Handed Molecules Simulates Achiral P21/n Packing via Pseudosymmetry. Cryst. Growth Des. 2011, 11, 1262–1270. [Google Scholar] [CrossRef]
- Monks, A.; Scudiero, D.; Skehan, P.; Shoemaker, R.; Paul, K.; Vistica, D.; Hose, C.; Langley, J.; Cronis, P.; Vaigro-Wolff, A.; et al. Feasibility of a high-flux anticancer drug screen using a diverse panel of cultured human tumor cell lines. J. Natl. Cancer Inst. 1991, 83, 757–766. [Google Scholar] [CrossRef]
- M100-S21; Performance Standards for Antimicrobial Disk Susceptibility Tests. Clinical and Laboratory Standards Institute: Wayne, PA, USA, 2011.
- Sari, S.; Avci, A.; Koçak, E.; Kart, D.; Sabuncuoglu, S.; Selin Dogan, I.S.; Özdemir, Z.; Bozbey, I.; Karakurt, A.; Saraç, S.; et al. Antibacterial azole derivatives: Antibacterial activity, cytotoxicity, and in silico mechanistic studies. Drug. Dev. Res. 2020, 81, 1026–1036. [Google Scholar] [CrossRef]
- Chauhan, D.P.; Varma, S.J.; Vijeta, A.; Banerjee, P.; Talukdar, P. A 1,3-amino group migration route to form acrylamidines. Chem. Commun. 2014, 50, 323–325. [Google Scholar] [CrossRef]
- APEX; Bruker. SAINT, and SADABS; Bruker AXS Inc.: Madison, WI, USA, 2007. [Google Scholar]
- Sheldrick, G.M. A short history of SHELX. Acta Crystallogr. 2008, A64, 112–122. [Google Scholar] [CrossRef]
- Sheldrick, G.M. Crystal structure refinement with SHELXL. Acta Crystallogr. 2015, C71, 3–8. [Google Scholar]
- Hübschle, C.B.; Sheldrick, G.M.; Dittrich, B. ShelXle: A Qt graphical user interface for SHELXL. J. Appl. Crystallogr. 2011, 44, 1281–1284. [Google Scholar] [CrossRef]
- Macrae, C.F.; Sovago, I.; Cottrell, S.J.; Galek, P.T.A.; Mccabe, P.; Pidcock, E.; Platings, M.; Shields, G.P.; Stevens, J.S.; Towler, M.; et al. Mercury 4.0: From visualization to analysis, design and prediction. J. Appl. Crystallogr. 2020, 53, 226–235. [Google Scholar] [CrossRef]
Disclaimer/Publisher’s Note: The statements, opinions and data contained in all publications are solely those of the individual author(s) and contributor(s) and not of MDPI and/or the editor(s). MDPI and/or the editor(s) disclaim responsibility for any injury to people or property resulting from any ideas, methods, instructions or products referred to in the content. |
© 2026 by the authors. Licensee MDPI, Basel, Switzerland. This article is an open access article distributed under the terms and conditions of the Creative Commons Attribution (CC BY) license.